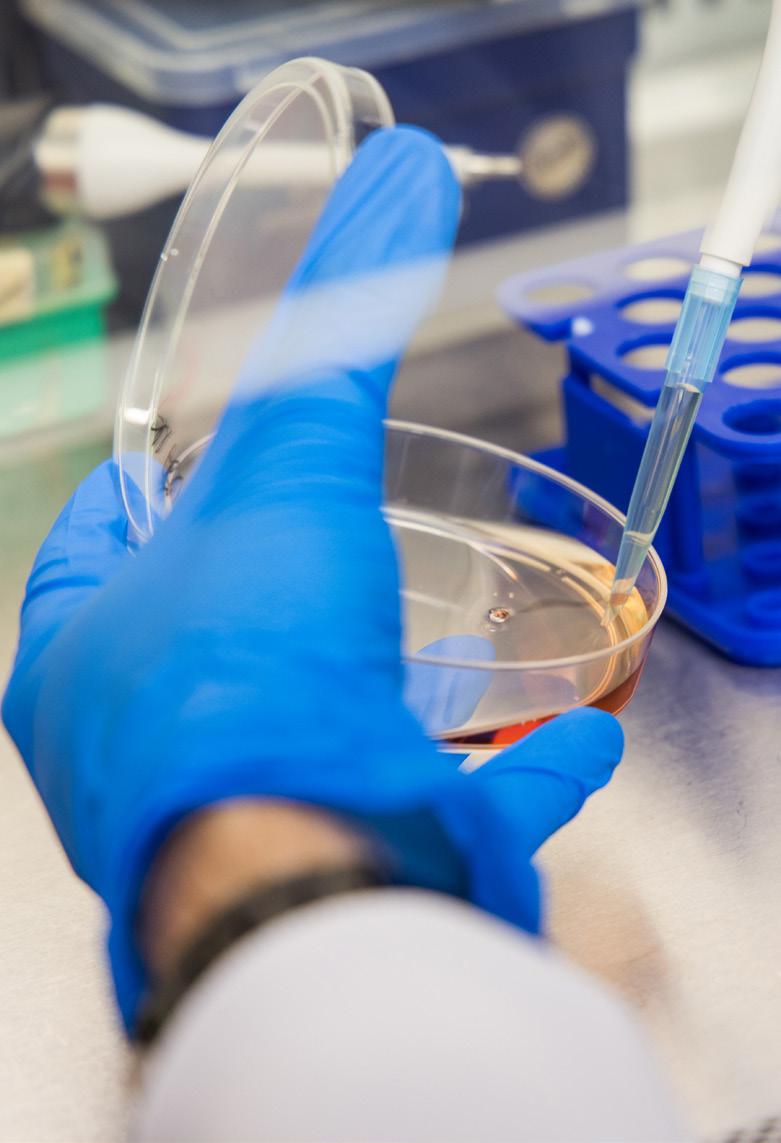

WE WILL FIND A CURE







TOGETHER
Annual Report and Financial Statements for the Year Ended 30th June 2022
Reference and Administrative Information
Registered Charity Number 1153487 (England and Wales).
Registered Charity Number SC046840 (Scotland).
Registered Company Number 08570737.
Registered Office and Headquarters: Suite 37, Shenley Pavilions, Chalkdell Drive, Shenley Wood, Milton Keynes MK5 6LB
Telephone number: 01908 867200
Website: www.braintumourresearch.org

Email: info@braintumourresearch.org
Trustees
Wendy Fulcher (Chairman)
D M Sandy Saunders BEM RD (President)
Rob Hughes (Deputy Chairman)
Jeremy Aron
Nigel Boutwood
Nicholas Dawe (resigned 5th May 2022)
Sukanta Ghosh

Jessica Ranft
Margaret Stockham Turner PhD
Bank
Nat West, 1 Penn Road, Beaconsfield, Bucks HP9 2PU
Leadership Team
Auditors Sayer Vincent LLP, Invicta House, 108-114 Golden Lane, London EC1Y 0TL
Chief Executive – Sue Farrington Smith MBE

Deputy Chief Executive and Director of Finance and Operations –Ashley Bailey ACMA
Director of Marketing and Communications –Andrea Abbis (appointed 2nd August 2021)

Director of Research, Policy and Innovation –Dr Karen Noble (appointed 1st February 2022)
Director of Fundraising and Supporter Care –Jason Rigby (left 28th February 2022)
Director of Income Generation and Development –Russell Marriott (appointed 6th June 2022)



Scientific and Medical Advisory Board
Professor Garth Cruickshank

MBBS PhD FRCS(Ed), FRCS (Eng), FRCS(SN) (Chairman)
Dr Neil Kad
Dr Sean Lawler
Professor Steven M. Pollard

Professor Dr Paolo Salomoni
Dr Khalid Shah
Report
Contents Reference and Administrative Information Chairman’s Report Chief Executive’s
Medical
Board Report Report of the Trustees Independent Auditor’s Report Statement of Financial Activities Balance Sheet Statement of Cash Flows Notes to the Financial Statements 2 3 5 7 8-27 28-29 30 31 32 33-45
Scientific and
Advisory
Margaret Stockham Turner PhD
Jessica Ranft
Rob Hughes Co-Founder (Deputy Chairman)
Sukanta Ghosh
Nicholas Dawe
Nigel Boutwood Co-Founder
Jeremy Aron
DM Sandy Saunders BEM RD Co-Founder (President)
Chairman’s Report
Along with the Board of Trustees I have been delighted to witness the Charity go from strength to strength over the last year, building on an impressive 2020-21. The Charity delivered £7.5 million income (2021: £5.3 million) a surplus of income over expenses of £1.4 million (2021: £1.3 million), further strengthening free reserves.
We continue to focus on finding a cure for all types of brain tumours through campaigning and fundraising. The Charity is now well-positioned to grow our network of sustainable Brain Tumour Research Centres of Excellence across the UK, with a fourth planned in 2022-23.
I was sorry to receive the resignation of Nick Dawe as Trustee due to competing priorities, and thank him for his significant contribution to developing our strategy whilst he was with us.
In Autumn 2021, with the support of an experienced facilitator, the Board and the Leadership Team revisited the results of our assessment survey, identifying areas to build on and gaps in our skills which we are now addressing.
Collaboration is at the heart of Brain Tumour Research and the Board was pleased to approve collaborations with both The Tessa Jowell Brain Cancer Mission and brainstrust to further two of our research pillars: Accelerating Treatments and Building Infrastructure.
Brain Tumour Research is proud to be funding the Brain Tumour Research Novel Therapeutics Accelerator (BTR-NTA) initiative, in partnership with the Tessa Jowell Brain Cancer Mission, as a route to finding cures more quickly.

BTR-NTA is a brand-new programme to review and provide guidance on the translation and development of novel drug treatments. It aims to bridge the gap between the promising research findings presented at conferences, published in journals, and hailed as the basis for possible future treatments and cures, and the number of these findings which progress into successful clinical trials.
We are partnering with Member Charity brainstrust to fund its Patient Research Involvement Movement (PRIME) which is focused on ensuring clinical research projects are aligned with the needs of patients. Despite the current economic climate, we anticipate being able to continue our growth strategy with the support of the strengthened Leadership Team and the Charity’s committed team. I would like to take this opportunity to recognise the hard work of the team, the commitment of the Board of Trustees and the continued loyalty of our supporters.
Together we will find a cure.

Brain Tumour Research – Registered Charity 1153487 (England and Wales) and SC046840 (Scotland). 3 Company Limited by Guarantee 08570737. Report of The Trustees and Accounts, Year Ended 30th June 2022
Wendy Fulcher, Co-Founder and Chairman
Income £7.5m up 40%
Delivered £1.4m surplus
OUR VISION
To find a cure for all types of brain tumours OUR MISSION
To increase the UK investment in brain tumour research


Values: Focused, Influential, Embracing, Game-changing and Intelligent

4 Brain Tumour Research – Registered Charity 1153487 (England and Wales) and SC046840 (Scotland), Company Limited by Guarantee 08570737. Report of The Trustees and Accounts, Year Ended 30th June 2022
Derek Thomas MP, Joanna Brown and Sue Farrington Smith MBE
Main image (L to R)
Front: Dr Karen Noble, Sue Farrington Smith MBE
Back: Russell Marriott, Andrea Abbis, Ashley Bailey
Selaine Saxby MP with our Stop the Devastation report
Investing in growth
Chief
Executive’s Report
We continued to deliver on our growth strategy, exceeding budget to achieve £7.5 million income, up over 40% on last year’s impressive performance. What’s more we were delighted to realise a surplus of £1.4 million and closing reserves of £2.5 million enabling us to launch a call for applications for a fourth Research Centre of Excellence. We are committing £2.5 million over five years for this new Centre. Selecting the new Centre will be a key activity during the rest of 2022 with its launch planned for March 2023.
I have been pleased to strengthen the Leadership Team during the year with the appointment of two new roles. Andrea Abbis joined in August 2021 as Director of Marketing and Communications and Dr Karen Noble joined us in February 2022 as Director of Research, Policy and Innovation. Jason Rigby left in February 2022, and we were delighted to recruit Russell Marriott as Director of Income Generation and Development in June 2022 with a particular focus on developing Corporate and Major Donor income streams. All three bring a wealth of experience and are already making a significant impact.
To ensure business continuity, we added Deputy Chief Executive to the responsibilities of Ashley Bailey, our Director of Finance and Operations. I feel we are in a much stronger position to deliver on our medium and long-term goals.
Our campaigning work goes from strength to strength, with our message about joined up thinking across Government funders getting through. Indeed, in conversation with a senior science minister in June 2022 he agreed that a “slow, bureaucratic, hierarchical and risk-averse funding ecosystem” has not served brain tumour patients and their families well – we are determined to change this.
As founders and providers of the secretariat for the All-Party Parliamentary Group on Brain Tumours, we are leading an important Pathway to a Cure inquiry and held six evidence sessions during the year. A report and recommendations to increase the national spend on funding brain tumour research is planned for early 2023.
Launched £2.5m call for fourth Centre of Excellence
Strengthened Leadership Team
Campaigning
More than 150,000 followers on social media
Leading Pathway to a Cure inquiry
We are supported by a loyal and committed team and have been able to invest in building the community fundraising and digital marketing teams in order to continue to grow our income and funds available to deliver our charitable objectives.
Our ever-growing base of loyal supporters continue to inspire us with their fundraising efforts and willingness to share their stories and raise awareness. We now communicate with more than 70,000 who have opted in to receive our communications as well as more than 150,000 followers on social media.
We are indebted to each and every one of our amazing fighting force of supporters. Together we will find a cure.
Now communicating to more than 70,000
Sue Farrington Smith MBE, Co-Founder and Chief Executive

Brain Tumour Research – Registered Charity 1153487 (England and Wales) and SC046840 (Scotland). 5 Company Limited by Guarantee 08570737. Report of The Trustees and Accounts, Year Ended 30th June 2022
for joined up thinking across Government funders
Helping Brain Tumour Research Centres of Excellence thrive and compete on the world stage





Evidence that starting treatment as early as possible after surgery produces the best results

Ground-breaking success in providing molecular characteristics for low-grade brain tumours
Model identifying specific driver genes abnormal in brain tumours widely acclaimed
Brain Tumour Research – Registered Charity 1153487 (England and Wales) and SC046840 (Scotland). Company Limited by Guarantee 08570737. Report of The Trustees and Accounts, Year Ended 30th June 2022
image
Professor Silvia Marino, Queen Mary University of London
Main
Dr Karen Noble, Director of Research, Policy and Innovation, Brain Tumour Research
University of Southampton
Mr Kevin O’Neill, Imperial College London
Dr Nelofer Syed, Imperial College, London
Professor Oliver Hanemann, University of Plymouth
Scientific and Medical Advisory Board Report

New Centre planned for 2023
BRAIN UK enabled 11 new brain tumour studies
The job of the Scientific and Medical Advisory Board (SMAB) is to provide a transparent, independent and authoritative assessment of research activity in the Brain Tumour Research Centres of Excellence. The process is governed by the rules of the Association of Medical Research Charities (AMRC) and the SMAB provides detailed feedback to Brain Tumour Research about how its money is being spent. The SMAB obtains reports from the Centres, reviews the scientific literature, audits the performance and finance, and uses independent and international peer reviewers to review these outputs against a global research view. In addition, we visit each Centre to gain further insight and understand how Brain Tumour Research can best help the Centres thrive and compete on the world stage of brain tumour research.
Most patients with brain tumours such as glioblastoma (GBM) will need radiotherapy. At Imperial College London, work has shown that exploiting metabolic pathways concerned with arginine metabolism can enhance the effect of radiation and we hope to see this tested in a clinical trial being developed by the Centre. There is evidence that starting treatment for brain tumours as early as possible after surgery produces the best results. With innovative surgical spectroscopy, surgeons at Imperial are investigating whether tumour signals can help identify tumour subtypes at surgery to allow immediate therapy to commence.
Many patients suffer with low-grade or slow-growing tumours such as meningiomas or schwannomas (acoustic neuroma). The team at the University of Plymouth has achieved ground-breaking success in providing molecular characterisation (HERVK) of these types of tumour. This offers the possibility of treating these tumours with new drugs currently being tested by the team. They have published key work on how these tumours form and grow and are using these data to explore such drugs as TAM receptor inhibitors and HDAC inhibitors.
At Queen Mary University of London, we were delighted to see that the model which was developed to identify the specific driver genes that are abnormal in tumours has been widely acclaimed. Comparator data from ‘normal’ iNSC and ‘tumour’ GIC cells such as transcriptome and DNA methylation, miRNA and histone tail changes has opened up the possibilities for therapeutic intervention in a novel and exciting way that is attracting international researchers to this Centre. The team is expanding its research to look at how identified molecular changes such as BMI1 may be exploited in childhood tumours. Work is also being conducted to investigate cell surface sugars as modulators of immune response.
A key component of all brain tumour research is access to tumour tissue taken from patients at surgery to establish the genetic and molecular abnormalities that make them tumours. BRAIN UK, based at the University of Southampton, with its comprehensive database and network, collates the UK collection of tumour tissue and storage to enable researchers to access this tissue. This vital resource has produced 11 new studies in the last year and 54 high-quality publications since 2014. These publications recognise the crucial role that BRAIN UK has played in enabling this research, so that each individual patient’s tumour adds essential information to our understanding and the potential to find cures.
We look forward to enlarging the portfolio of Brain Tumour Research’s research success with a new Centre in 2023. I am very grateful to all those involved with the SMAB who have given their time to this exciting programme.
Professor Garth Cruickshank MBBS PhD FRCS(Ed), FRCS (Eng), FRCS(SN) Chairman of Brain Tumour Research, Scientific and Medical Advisory Board

Brain Tumour Research – Registered Charity 1153487 (England and Wales) and SC046840 (Scotland). 7 Company Limited by Guarantee 08570737. Report of The Trustees and Accounts, Year Ended 30th June 2022
Trustees’ Annual Report
Objectives and Activities
Our Aims




Our vision is to find a cure for all types of brain tumours, and our mission is to increase the UK investment in brain tumour research and build a network of experts in sustainable brain tumour research. We work with Parliamentarians to raise awareness about brain tumours and to influence national cancer policy at the highest levels as we campaign to increase national investment for research into this devastating disease to £35 million per annum and bring parity with other cancers such as breast and leukaemia.
We believe that with sustainable long-term funding, we can build capacity at our Brain Tumour Research Centres of Excellence such that they are able to recruit and train more promising researchers who might otherwise be attracted into other cancer research areas which have traditionally attracted greater funding and with it, greater prospects and job security. Over time, as specialist brain tumour expertise and knowledge builds, it is our plan that researchers who are experienced and knowledgeable in the field will move between Centres to support ‘cross-pollination’ of the very best thinking at the cutting-edge of brain tumour research.
With a growing ability to build outstanding teams of collaborative researchers amongst the academic and medical communities, we believe our Centres of Excellence are well-placed to develop long-term strategic research plans to explore new avenues and potentially find the key breakthroughs that patients and their families so desperately need.
Each Centre of Excellence is an active partner with Brain Tumour Research. We support those Centres by providing dedicated members of the Charity’s staff with expertise in fundraising, marketing and PR to work at a local and national level. This co-operation and dedication to the brain tumour cause supports and enhances the identity of each Centre as well as that of Brain Tumour Research, providing a dynamic fundraising atmosphere with the goal to help each Centre ultimately raise at least £1 million per year, to support sustainable research.


Our Centres form part of a national network collaborating with each other and other institutes, both within the UK and internationally, in order to accelerate progress in brain tumour research and ultimately make a real clinical difference. We partner with researchers and clinicians who share our vision of a sustainable and secure future for UK brain tumour research. We believe this will help to deliver the better future for all those living with a brain tumour that we are so determined to achieve.
Collaboration is one of our core values and the number of registered charities which have joined forces with us to raise awareness and campaign as one voice numbered 24 at the end of the year. We aim to work with Member and other charities to continually grow the market for brain tumour fundraising in the UK in order to increase the investment into brain tumour research and expand the specialist information and support that our Members provide to those diagnosed with a brain tumour and their families..
Collaborating with 24 Member Charities –campaigning as one voice

Our Charitable Objects are for the Public Benefit
To assist in the relief of sickness and distress of persons suffering from brain tumours particularly by supporting research projects into the causes and treatment of brain tumours and disseminating the useful results of such research.



The Charity operates throughout England, Wales, Scotland and Northern Ireland.


The Trustees have referred to the guidance contained in the Charity Commission’s general guidance on public benefit when reviewing the Charity’s aims and objectives and in planning its future activities. In particular, the Trustees consider how planned activities will contribute to the aims and objectives that have been set.

8 Brain Tumour Research – Registered Charity 1153487 (England and Wales) and SC046840 (Scotland). Company Limited by Guarantee 08570737. Report of The Trustees and Accounts, Year Ended 30th June 2022
The Trustees of Brain Tumour Research, who are also directors of the Charity for the purposes of the Companies Act, present their Annual Report and audited financial statements for the year ended 30th June 2022.
Structure, Governance and Management
The Charity is a charitable company limited by guarantee and was originally known as The Diana Ford Trust and registered on 14th August 2002. In 2005, The Diana Ford Trust joined an informal partnership of UK brain tumour charities known as The United Brain Tumour Campaign. In 2008, the Charity formalised this relationship and amended its name, to better demonstrate its objectives, to Brain Tumour Research.
The Trustees who served during the year ending June 2022 were:
Wendy Fulcher (Chairman)
DM Sandy Saunders BEM RD (President)
Rob Hughes (Deputy Chairman)
Jeremy Aron
Nigel Boutwood
Nicholas Dawe (resigned 5th May 2022)
Sukanta Ghosh
Jessica Ranft
Margaret Stockham Turner PhD
Members of the Charity guarantee to contribute an amount not exceeding £10 to the assets of the Charity in the event of winding up. The total number of such guarantees at 30th June 2022 was nine (2021: 10). The Trustees are members of the Charity but this entitles them only to voting rights. The Trustees have no beneficial interest in the Charity.
The Remuneration Committee meets to review the remuneration policy and the pay and benefits of the Charity’s employees. The Finance, Audit and Risk Committee meets in accordance with its purpose to assist the Board in its duty to supervise the broad direction of the Charity’s financial affairs and to oversee the audit and risk management processes. The Research Committee meets to consider new programmes, review existing programmes and receive research reports. The Fundraising and Communications Working Group meets as required to review emerging trends in the sector, to satisfy the Trustees that fundraising activities and communications are appropriate and in accordance with the law and compliant with the regulations of relevant fundraising bodies.
Governing Documents
Declaration of trust made 17th July 2002 as amended 4th April 2008 and 9th December 2008 and Memorandum and Articles of Association dated 14th June 2013.
Appointment, Induction and Training of Trustees
New Trustees are appointed by a resolution of the existing Trustees. In selecting potential Trustees, the Trustees take into account the benefits of appointing a person who through lived experience, residence, occupation, employment or otherwise has special knowledge of the area of benefit or who is otherwise able by virtue of his or her personal or professional qualifications to make a contribution to the pursuit of the objects or the management of the Charity.
Potential Trustees are identified through advertising in relevant publications, recommendations from Member Charities and approaches (informal or formal) to the Charity. They are scrutinised by at least three serving Trustees.
On appointment, all new Trustees receive thorough induction and training, which includes receiving detailed information about the Charity via a Trustee Induction Pack, including its Memorandum and Articles, latest accounts, latest financial reports and minutes of recent Trustees’ meetings. In addition, new Trustees attend an induction process at head office, where they are briefed by the Chief Executive and key staff on all aspects of the Charity’s operations, staffing and organisational management. Trustees are encouraged to attend appropriate external training events where these will facilitate the undertaking of their role.
Management
The Trustees have always sought to develop a professional, well managed and proactive charity in line with good business practice. Trustees oversee governance, agree strategy and the direction of the Charity, they approve financial accounts, budgets and reserves and approve research grants and risk management policies.
The Trustees delegate the day-to-day management of the Charity to the Leadership Team, as detailed on page 2.
Following the recent success and growth of the Charity, this year saw the addition of two key leadership roles. In August 2021, the Charity appointed its first Director of Marketing and Communications, and in February a Director of Research, Policy and Innovation. After the departure of the Director of Fundraising and Supporter Care in February 2022, the Charity replaced the position with a Director of Income Generation and Development, who commenced in June 2022.
The Key Management Personnel comprise the Trustees and the Leadership Team.
Remuneration Policy
The Trustees are not remunerated. The Charity is committed to ensuring that it pays its employees fairly and in a way which ensures it attracts and retains the right skills to have the greatest impact in delivering its charitable objectives. As such, its principles are to pay a fair salary and offer benefits that are competitive within the charitable sector and the local employment market, as well as affordable, proportionate to the complexity and technical demands of each role, and in line with organisational objectives.
The Charity reviews the salaries of all staff annually in July, with the Board of Trustees approving the percentage rates for any baseline or higher rate increases. A salary review does not imply an increase and, in making any pay award, the review will be based on affordability and the Charity’s financial health. The remuneration policy, applicable to all team members, is reviewed annually and the Remuneration Committee oversees its application, providing advice to the full Board.
AGM
The AGM is held at the annual Members’ Workshop – the agenda includes Presentation of the Financial Statements for the prior year, a verbal update of where the Charity is presently, developments in strategy, and a welcome to any new Members and Trustees. Due to the pandemic, this was held virtually again in 2021.
Brain Tumour Research – Registered Charity 1153487 (England and Wales) and SC046840 (Scotland). 9 Company Limited by Guarantee 08570737. Report of The Trustees and Accounts, Year Ended 30th June 2022
Operations and Financial Review
Achievements and Performance – Research
This year we granted a further £2.6 million to our three Research Centres of Excellence and BRAIN UK, the virtual brain tumour tissue registry based at the University of Southampton. The continuing success of our research programmes is highlighted by the increasing number of significant publications produced from the work of the Research Centres and BRAIN UK.
We were pleased to see that overall spend on brain tumour research in the UK continued to increase, reaching £17.6 million in 2020/21, as reported by the National Cancer Research Institute (NCRI). Nevertheless, there is a long way to go before our campaigning goal is reached, in which national funding for brain tumour research exceeds £35 million per annum.
The University of Plymouth, home to our Centre directed by Professor Oliver Hanemann, also had cause to celebrate with 78% of their submissions assessed as world-leading or internationally excellent.
We have also initiated two important partnerships this year. The first is Patient Research Involvement Movement (PRIME) in partnership with brainstrust. There is unprecedented demand from the clinical and research community for public input into trial and research proposals. This ensures the goals and methods reflect what people want when they are living with a brain tumour. Funding is now inaccessible without this patient and public perspective. Patient and public involvement and engagement (PPI&E) is key to attracting funding for research and by 2022 PRIME has already helped to attract more than £17 million of investment by matching scientists and clinical researchers with brain tumour patients.
The vision of brainstrust is for everyone with a brain tumour to feel less afraid, less alone, and more in control and, through PRIME, it is bringing people with direct experience of life with a brain tumour into contact with the clinical research community where they can have direct input and help shape studies and secure funding for research and clinical trials.
For clinical and research communities, PRIME streamlines co-production, co-participation and engagement-based activities. It brings together PPI&E managers, coordinators, patients, clinical researchers, under-represented groups and other stakeholders to support relationship building and inclusivity of communities and participants in research.
This year, as part of the Research Excellence Framework*, the UK-wide assessment of university research, all staff with a “significant responsibility” for research were entered for assessment. Imperial College London, the host university for one of our Centres of Excellence, was ranked at the top amongst universities in the UK. The Department of Brain Sciences, in which our Centre is based, also scored top, when compared to other units researching Psychology, Psychiatry and Neuroscience. There was good news from Queen Mary University of London too, where our Centre, headed by Professor Silvia Marino, is located. In clinical medicine, 90% of the research was rated as world-leading or internationally excellent, and in the top 10 for research power.
Brain Tumour Research is also proud to be providing the initial funding of £131k for the Brain Tumour Research Novel Therapeutics Accelerator (BTR-NTA) initiative, in partnership with the Tessa Jowell Brain Cancer Mission, as a route to finding cures more quickly. BTR-NTA is a new programme to review and provide guidance on the translation and developments of novel drug treatments. It aims to bridge the gap between the promising research findings presented at conferences, published in journals, and hailed as the basis for possible future treatments and cures, and the number of these findings which progress into successful clinical trials. Guided by a unique multi-disciplinary international group of academic, industry drug development and regulatory experts, applicant researchers
10 Brain Tumour Research – Registered Charity 1153487 (England and Wales) and SC046840 (Scotland). Company Limited by Guarantee 08570737. Report of The Trustees and Accounts, Year Ended 30th June 2022
Further £2.6m granted to our three Research Centres of Excellence
Reference:
£0m £5m £10m £15m 2002/03 2020/21 2003/04 2004/05 2005/06 2006/07 2007/08 2008/09 2009/10 2010/11 2011/12 2012/13 2013/14 2014/15 2015/16 2016/17 2017/18 2018/19 2019/20 Expenditure in research relevant to brain tumours
National spend on brain tumour research reached £17.6m
*www.ncri.org.uk/how-we-workcancer-research-database/trends-in-disease-site-spend
Initiated two important partnerships
will receive bespoke feedback on the development path for therapeutics for brain tumour diseases.
The programme provides infrastructure to ensure the most promising therapies reach patients as quickly as possible through a confidential review and go/ no-go milestones. Applicants will have the opportunity to use the committee reports to support subsequent funding applications or discussions. The aim of each review is to identify potential pitfalls in clinical trial design and give independent, transparent advice in order to help the applicant position the candidate compound along a realistic and well-informed pathway to clinical trial and eventual registration. It is expected that the programme will see more agents successfully enter into human trials, more research focused on drug discovery encouraged and stimulated, improved relationships with industry and academia, and de-risking of trials.
Research Strategy
Brain Tumour Research is dedicated to funding continuous and sustainable scientific research into brain tumours. This is vital if we are to achieve our vision of finding a cure for brain tumours and building a network of experts in sustainable brain tumour research.
We aim to:
• Grow capacity
– Review strategy including identifying gaps in research by brain tumour types and identifying new research priorities
– Establish seven Research Centres of Excellence across the UK
Collaborate nationally and internationally
Encourage financial support for our Research Centres of Excellence from collaborators
•Build infrastructure
Improve co-ordination across the UK brain tumour research community
Expand use of the BRAIN UK tissue registry
– Host annual workshops focused on priority areas
Sponsor the British Neuro-Oncology Society and other relevant international conferences
Influence National Cancer Research Institute priorities
• Accelerate treatments
Produce research impact reports
– Improve research quality through rigorous peer review
Introduce a Public Patient Involvement programme
Help Centres translate knowledge and targets into new clinical trials
– Generate and exploit Intellectual Property Rights
Our Centres at the University of Plymouth, Queen Mary University of London and Imperial College London provide an environment where the most promising scientists are provided with the experience and opportunities for career development needed in order to fulfil their performance potential. This facilitates the development of a strong neuro-oncology research base in the UK and encourages researchers to remain in the brain tumour field rather than being tempted away into other areas of cancer research that currently attract greater funding.
Our longer-term sustained funding is also strengthening researchers’ applications for project and career-development grants from larger funding bodies such as the Medical Research Council (MRC), the National Institute for Health Research (NIHR) and Cancer Research UK, with increasingly successful grant applications being enjoyed across our Centres.
By building outstanding teams of collaborative researchers within the academic and medical communities, our Centres of Excellence facilitate the development of long-term strategic research plans to explore promising new avenues. As the critical mass of high-quality scientists builds, our Centres are attracting outstanding researchers from across the globe, bringing with them expertise from a wide range of backgrounds whilst simultaneously increasing opportunities for new collaborations. This will bring us closer to finding that key breakthrough that the brain tumour world so desperately needs.
All Brain Tumour Research Centres of Excellence are taken through a rigorous annual review, led by the Scientific and Medical Advisory Board and chaired by Professor Garth Cruickshank. This ensures that we are investing in high-quality, peer-reviewed research that best serves the interests of patients, scientists and clinicians, and provides the best basis for effective clinical trials and eventually new therapies that will bring us closer to a cure for brain tumours.
For more information on our research strategy, please visit our website: www.braintumourresearch.org/research-strategy

Brain Tumour Research – Registered Charity 1153487 (England and Wales) and SC046840 (Scotland). 11 Company Limited by Guarantee 08570737. Report of The Trustees and Accounts, Year Ended 30th June 2022
–
–
–
–
–
–
–
–
–
Brain tumour growth in live fruit fly model at the University of Plymouth.
Credit Dr Claudia Barros
Developing a strong neuro-oncology research base in the UK
Building outstanding teams of collaborative researchers
Operations and Financial Review (continued)
Queen Mary University of London

The Brain Tumour Research Centre at Queen Mary University of London is a partnership between The Blizard Institute at Queen Mary and The National Hospital for Neurology and Neurosurgery, Queen Square, London. The main goals of the Research Centre at Queen Mary are to develop novel therapeutic approaches for brain tumours. The team primarily focuses on research into glioblastoma (GBM), the most common and aggressive form of brain tumour in adults. The Research Centre is also applying innovative approaches to develop new treatments for childhood tumours such as medulloblastoma and ependymoma tumours.
The Research Centre at Queen Mary has established an entirely new experimental research pipeline to collect and analyse cells derived from brain tumour tissue. Using a combination of laboratory work and sophisticated analytical computer programs, the team is already identifying key molecular differences that can potentially be exploited to find a cure.




This new system enables the comparison of normal and malignant cells from the same patient, helping to identify genes that play a role in GBM growth. Using this technique, they study changes in the function of genes that do not entail a change in the genetic code (epigenetics). This clever method seeks to identify new targets for individualised drug treatments.

Using this pipeline in a trial involving 10 patients, the team revealed new insights into how GBM develops, identifying potential new targets for individualised treatments. It could also help predict a patient’s response to drugs currently in clinical use for other diseases, which would be extremely valuable as the average survival time for
GBM is just 12 to 18 months. Their paper, Comparative epigenetic analysis of tumour initiating cells and syngeneic EPSC-derived neural stem cells (SYNGN) in glioblastoma, was published in the high impact journal Nature Communications
Research focused on medulloblastoma – the most common highgrade brain tumour in under 16s – showed that those with a specific sub-type of the disease could benefit from a new combination of treatment. If further studies are positive, it could see children with this tumour subtype treated with a new combination of drugs which it is hoped would prove less harmful and lead to a better quality of life. The study is published by the journal Neuro-oncology
The Research Centre at Queen Mary has been very successful in securing additional funding from the University and from elsewhere. On top of the £4 million awarded to the Centre by Brain Tumour Research, it has secured a further £11 million from other sources including Queen Mary, Cancer Research UK, the National Institute for Health Research (NIHR) and the Barts and the London Charity. With research income totalling £11 million, every £1 awarded by Brain Tumour Research has leveraged a further £2.75 from other sources.
Brain Tumour Research – Registered Charity 1153487 (England and Wales) and SC046840 (Scotland). Company Limited by Guarantee 08570737. Report of The Trustees and Accounts, Year Ended 30th June 2022
£4 million
–
0 1 2 3 4 5 6 7 8 9 10 11 leveraged £11m additional Funding in £ millions £4m invested
invested in Queen Mary which leveraged a further £11million
that’s £2.75 for every £1 invested by Brain Tumour Research
Professor Silvia Marino
Article published in Nature Communications in 2021
Left: Research students at work in the dedicated labs. Right: Main laboratory at Queen Mary
University of Plymouth
The Research Centre at the University of Plymouth concentrates on low-grade brain tumours, particularly meningioma, which is the most common primary intracranial brain tumour. Led by Professor Oliver Hanemann, the Centre incorporates three research groups investigating how tumours initially arise and how low-grade tumours develop into higher grade ones.

A further aim of the Research Centre is to identify biomarkers that are linked to low and high-grade tumours, enabling the stratification of tumours into specific subtypes. The Centre also seeks to identify and validate new drug targets for meningioma using cell culture models.

The Centre has strong links with clinicians at the local hospital in Plymouth and also in Bristol. The Brain Tissue Biobank at the University of Plymouth holds tumour tissue, blood and associated clinical data, facilitating translation into clinic.

This year the Centre has published four manuscripts. These include reporting on a new breakthrough that could see drugs developed to treat AIDS and HIV used to treat low-grade brain tumours. The discovery is significant because, if further research is conclusive, the anti-retroviral drugs could be prescribed for patients diagnosed with meningioma and acoustic neuroma (also known as schwannoma).

In this study the team investigated the role that specific sections of our DNA play in tumour development. Named ‘endogenous retrovirus HERV-K’, these sections of DNA are relics of ancient infections that affected our primate ancestors, which have become stable elements of human DNA. The team showed that high levels of HERV-K proteins were present in meningioma and schwannoma cells obtained from patients. The team was also able to identify molecular events that may enable HERV-K proteins to stimulate the growth of these tumours. Furthermore, several drugs were identified that target these proteins, reducing the growth of schwannoma and grade 1 meningioma cells in the laboratory. Significantly, these drugs – the retroviral protease inhibitors ritonavir,

atazanavir, and lopinavir – have already been approved for use in the treatment of HIV/AIDS in the USA and are also available in the UK. These results revealed HERV-K proteins to be critical regulators of growth in tumours that are deficient in Merlin.
Another paper, published in the influential journal Neurology, highlights the importance of personalised medicine in developing more effective, targeted treatments for the nervous system disorder neurofibromatosis (NF). The publication is of significant interest to the brain tumour community because as many as 9% of patients diagnosed with a particular form, NF1, go on to develop brain stem glioma. It describes how our increasing understanding of the genetic changes that contribute to NF1 and NF2 can be valuable for identifying specific subtypes of disease. This seems to be more straightforward for NF2, where analysis of known genetic changes has helped to devise the severity score (mild/moderately severe/severe).
This year, the Research Centre at Plymouth has been very successful in attracting over £1.8 million in funding from a range of sources, including government and charities.
 Professor Oliver Hanemann the University of Plymouth
Professor Oliver Hanemann the University of Plymouth
Brain Tumour Research – Registered Charity 1153487 (England and Wales) and SC046840 (Scotland), 13 Company Limited by Guarantee 08570737. Report of The Trustees and Accounts, Year Ended 30th June 2022
Discovery research at the University of Plymouth laboratory
Operations and Financial Review (continued)
Imperial College London
The Research Centre at Imperial College London undertakes an array of interlinked laboratory, computational, artificial intelligence and clinical projects. The close collaboration between the research laboratories at Imperial College London and Imperial College Healthcare NHS Trust, particularly Charing Cross Hospital, places them in a strong position to ensure that basic laboratory science is quickly translated into the clinic where patients can benefit from their cutting-edge research.
Led by Consultant Neurosurgeon Mr Kevin O’Neill and Dr Nelofer Syed, the Research Centre has developed a systems biology approach, applying artificial intelligence, computational and mathematical models of complex biological systems to help understand how brain tumour cells function, and how they can be manipulated to cure this disease. This use of artificial intelligence enables them to quickly investigate key pathways and genetic mutations that drive brain tumour growth and identify ways to sensitise tumours to existing therapies (hence making them more effective, potentially at lower doses to reduce side effects). They also have a strong focus on exploring existing drugs currently used for other diseases that affect cancer pathways and hence could quickly be repurposed for use in brain tumours, as they are ideally placed to test such drugs in preclinical and early phase clinical trials.
Key publications this year include research published in the Journal of Clinical Investigation which showed a potential new treatment that could dramatically improve the effectiveness of radiotherapy for patients diagnosed with the most common and deadliest form of brain tumour.

The team found that a drug which depletes the amino acid arginine made glioblastoma (GBM) tumours much more susceptible to radiotherapy.

A second paper, published in the journal PNAS, identified a new potential tarzget known as angiotensin II type 2 receptor (AT2R). The researchers have shown that when angiotensin II binds to its receptor AT2R, on GBM cells, there is a proliferation and invasiveness of the cancer cells. In studies in the lab, they were able to successfully inhibit tumour growth in GBM by blocking the receptor’s activity using a re-purposed drug called EMA401 which was developed for the management of peripheral neuropathic pain.

Nearly £0.5 million additional funding has been secured by the Centre at Imperial College London this year from other

14 Brain Tumour Research – Registered Charity 1153487 (England and Wales) and SC046840 (Scotland). Company Limited by Guarantee 08570737. Report of The Trustees and Accounts, Year Ended 30th June 2022
Potential new treatment that could dramatically improve the effectiveness of radiotherapy
Studies able to successfully inhibit tumour growth in GBM
Dr Nelofer Syed Imperial College Healthcare NHS Trust
Mr Kevin O’Neill
Researcher working with microplates at Imperial College London
Imperial College laboratory
BRAIN UK
One of the biggest barriers to finding a cure for brain tumours is the lack of, and difficulty in acquiring, the tissue needed for innovative research. Researchers can often be held back by lengthy application processes, delaying research and preventing neuro-oncological research for which tissue samples are critical for understanding brain tumours and identifying targets for new drugs within tumour cells. Recognising a huge unmet scientific and clinical need for brain tumour tissue, Helen Bulbeck at our Member Charity brainstrust led a partnership of charities and hospitals to establish BRAIN UK in 2014 in order to streamline the process of making brain tumour tissue available to researchers.
BRAIN UK is a virtual brain bank that makes tissue samples available to the research community for high-quality neurological research. It catalogues samples from participating NHS Neuropathology Centres in a centralised database. BRAIN UK provides access to over 140,000 biopsy and almost 37,000 postmortem cases, unlocking thousands of previously hard to access brain samples for researchers throughout the UK and internationally.

Initially started in 2009 to enable access to post-mortem cases, the tissue bank was extended in 2014 to include biopsies – tissue samples taken at operation from living patients. Many studies have been completed over the last eight years with results presented at conferences and published.

BRAIN UK has supported 72 brain tumour studies since it began. More than 8,300 cases have been approved for use. 62% of researchers say their studies could not have been conducted without BRAIN UK, and most of the others say that the resource has had a significant impact.
229 outputs generated from the brain tumour studies
17 new papers published in peerreviewed journals in 2021
Journals: Cancer Discovery and Neuropathy and Applied Neurobiology

To date, 229 outputs have been generated from the brain tumour studies. These include 54 publications in peer-reviewed journals, including the Nature and Lancet, Cancer Discovery and Cancer Research journals.
Seventeen new papers were published in peer-reviewed journals in 2021. A particular highlight for 2021 was the paper by Clarke and colleagues, published in 2020 in the high-profile journal Cancer Discovery which has contributed to the creation of a specific chapter in the new 2021 WHO Classification of CNS Tumours. 33 cases were provided for this multi-author multi-centre international study, aiding collection of the largest series of infant gliomas to date. Application of methylation profiling and sequencing resulted in the identification of new categories of childhood high-grade gliomas, differing in outcome and with identification of new therapeutic targets. This study has changed the diagnostic practice and management for these children who currently have a poor prognosis. There was also a publication of a review describing how BRAIN UK operates and its successes to date in the journal Neuropathology and Applied Neurobiology, “BRAIN UK: Accessing NHS tissue archives for neuroscience research”.



Brain Tumour Research – Registered Charity 1153487 (England and Wales) and SC046840 (Scotland). 15 Company Limited by Guarantee 08570737. Report of The Trustees and Accounts, Year Ended 30th June 2022
62% of researchers say their studies could not have been conducted without BRAIN UK
Professor James Nicoll
Aided collection of the largest series of infant gliomas to date
Cell image: Fluorescent microscope images of melanoma brain metastasis tumours.
Credit: Dr Aithne Atkinson, Imperial College
Operations and Financial Review (continued)
Achievements and Performance –Campaigning and Raising Awareness
People cannot support a campaign unless they know it exists and this year, we have added more than one new campaigner per day (375) to our database which now has 1,150 supporters receiving weekly campaigning updates. We now have active political brain tumour research supporters in over 78% of UK constituencies (510 of the 650 total).
In July 2021, the then Prime Minister, Boris Johnson, received our Stop The Devastation report. Presented to him by Derek Thomas MP (Chairman of the Brain Tumour All Party Parliamentary Group), this handover had been agreed in March when Derek spoke at Prime Minister’s Questions (PMQs) and drew MPs attention to Brain Tumour Awareness Month.


Following the handover, Derek joined a meeting we had set up with The Wanted singer Tom Parker and others, including Holly Mumby-Croft MP and Lord Polak, at the Methodist Central Hall in Westminster.

At December’s meeting of the All-Party Parliamentary Group on Brain Tumours (APPGBT), Tom Parker opened the proceedings speaking about his own diagnosis with a glioblastoma (GBM) in October 2020. He said: “I’m staggered they can find a cure for COVID-19 within a year but can’t find better treatments and ultimately a cure for brain tumours for decades on end.” Tom sadly died in April 2022. That December APPGBT meeting closed with an update on the Pathway to a Cure – breaking down the barriers inquiry. Our Chief Executive told the attending Parliamentarians “It is high time that brain tumour research is given parity with other cancers such as leukaemia and breast cancer. This inquiry will break down the barriers and provide the pathway to achieving this.”
In February, as part of the inquiry, we issued a call for evidence to researchers and clinicians working on brain tumours. We engaged the support of BRAIN UK, and professional bodies such as the British Neuro-oncology Society (BNOS), the Society of British Neurological Surgeons (SBNS), Queens Square and Cancer Research UK Cambridge Centre to make sure we reached as many potential respondents as possible. Thirty-eight individuals responded to the call for evidence from 26 organisations.
In March, there were two oral evidence sessions for the APPGBT inquiry, and panel members heard from witnesses representing both clinical and lab-based research. Subjects explored included research funding, conducting clinical trials, priorities for research and barriers to a sustainable career.
Links to Stormont were also made immediately after the APPGBT when Brain Tumour Research and Derek Thomas met with a member of Northern Ireland’s Legislative Assembly, Cara Hunter MLA, who is also a brain tumour patient.
The fourth oral evidence session of the inquiry was held virtually in April and panel members heard from the paediatric brain tumour research community. Varied topics came under the spotlight ranging from the accessing and availability of clinical trials to brain injury and rehabilitation.
Later that day, a powerful debate highlighting childhood cancer outcomes took place at Westminster. We were pleased to provide briefing notes to Members contributing to this passionate and timely debate.
At the APPGBT’s AGM in May, Derek Thomas MP was re-elected as Chair and the APPGBT was strengthened by adding new officers, Lord Polak and Jane Hunt MP, to its existing roster of supportive Parliamentarians. On his re-appointment Derek said: “It is the aim of all of us involved in the APPGBT to make a difference. It is a cause we all care very deeply about.”
Also in May, the APPGBT inquiry held its oral evidence from industry session. A wide-ranging discussion incorporated a “fundamental flaw” in drug development when new drugs have to produce better results than all other drugs currently on the market, problems with clinical trial design and the changes in regulation coming into force with the Medicines and Healthcare products Regulatory Agency which could create “an opportunity to reinvent the system”.
Later that month, 650 of our exclusive Queen’s Platinum Jubilee Crown pin badges were given to all MPs who take their seats at Westminster and were worn by many in the chamber for the final PMQs before the Platinum Jubilee celebrations.
16 Brain Tumour Research – Registered Charity 1153487 (England and Wales) and SC046840 (Scotland). Company Limited by Guarantee 08570737. Report of The Trustees and Accounts, Year Ended 30th June 2022
Prime Minister Boris Johnson is presented with our Stop the Devastation report by Derek Thomas MP
MPs wearing our commemorative crown pin badges in Westminster
L to R: Holly Mumby-Croft MP, Derek Thomas MP, Dave Bolton, Tom Parker, Maria Realf, Lord Stuart Polak
In June, the then Secretary of State for Health and Social Care, Sajid Javid MP, was questioned by MPs and Holly Mumby-Croft MP took the opportunity to tell the Secretary of State that improved access was needed to the £40 million brain tumour research funding made available by the Government in 2018. She asked Sajid Javid if he would read the inquiry report of the APPGBT and if he will do all he can to speed up access to the £40 million.

His reply was: “I will of course read the APPG report that she referred to” and that “I am determined to ensure the funding that we’re investing in this vital area of research is going straight to the front line”


The inquiry report will be compiled by Brain Tumour Research as part of their role as secretariat for the APPGBT and, once all panel members have given feedback and approved content and recommendations, it will be launched in early 2023.

At Brain Tumour Research, we are committed to identifying and removing any barriers to the deployment of all of this £40 million and are very grateful to the politicians who support us in this endeavour and our campaigners who tenaciously and persistently lobby them. As Minister with responsibility for the Life Sciences, George Freeman MP takes a very personal interest in this money as it was following his response on behalf of the Government at the Westminster Hall brain tumour debate in 2016 that this money became available for deployment. We had the opportunity to explain fully the current allocation situation to George in June and he asked us to document this in a letter we drafted and he then sent to Health Minister Lord Kamall.
We are grateful to all those that support our cause, and especially Sajid Javid and George Freeman, who are powerful advocates for Brain Tumour Research.
We continue to be involved with relevant campaigning and professional organisations, such as Cancer52 (including as a member of its Policy and Public Affairs Steering Group), Scottish and Welsh Cancer Coalitions, the Joint APPG Secretariat Group, Association of Medical Research Charities (AMRC), SBNS, BNOS and Children and Young People’s Cancer Coalition (as a member of the steering group). We are also a partner of the National Cancer Research Institute (NCRI), a member of the National Health Service England Cancer Charities Forum and the Neurological Alliance.




We continue to exert our influence, calling for increased national investment for research into brain tumours and ultimately to



Brain Tumour Research – Registered Charity 1153487 (England and Wales) and SC046840 (Scotland). 17 Company Limited by Guarantee 08570737. Report of The Trustees and Accounts, Year Ended 30th June 2022
Above: George Freeman MP with supporter Stuart Grant
1,150 supporters receiving weekly campaign updates Active political supporters in over 78% of UK constituences
Derek Thomas MP
Operations and Financial Review (continued)
Achievements and Performance –Fundraising


As we finally emerged from the restrictions of COVID-19, events and fundraising were able to return to ‘normal’ and whilst this was a welcome relief to most, it did create a time of uncertainty regarding the fundraising landscape and resilience of our donors. However, the full-year picture was very positive – income of £7.5 million was £2.2 million better than the previous year –with a surplus of £4.1 million before grant commitments.
We continued to grow the database each month and have now exceeded 200,000 contacts. This year, the main driver for the growth in the email opt-ins have been donors on Just Giving and participants of our Facebook fundraising campaigns.
In the Eastern Region of our Community Fundraising team, a Walk of Hope held in Luton, in conjunction with the Fundraising Group Fight4Hope raised circa £15k, and our Charity of the Year partnerships raised over £60k. In the Western Region, the team was vital in the recruitment of our first £1million donor and the setting up of several new Fundraising Groups. In the Northern Region, the team organised two Yorkshire Three Peaks events in May and June raising nearly £60k, and secured a new Fundraising Group Stronger Together For Nicola which raised over £35k.

After a slow and uncertain start, the year ended very positively for our events’ fundraising activities, despite the postponement once again of a planned London Marathon (in April 2022).

Trusts and Foundations delivered £361k, including £150k from our Member Charities, and over £50k from our partnership with the Lions Clubs International
We also received £326k from a scheme set up by the Department of Business, Energy and Industrial Strategy and administered by UK Research and Innovation to protect the careers of young researchers potentially affected by a reduction in research funding as a result of Covid-19.
Despite the encouraging year-on-year growth in income, we believe there remains scope to grow a number of income streams under the leadership of our new Director of Income Generation and Development.
18 Brain
Research
and Accounts, Year
30th June 2022
Tumour
– Registered Charity 1153487 (England and Wales) and SC046840 (Scotland). Company Limited by Guarantee 08570737. Report of The Trustees
Ended
As always, we want to extend our thanks to all our supporters!
Fight4Hope Fundraising Group raised £15k
Eastern Region Charity of the Year partners raised over £60k
Stronger Together for Nicola over £35k
Amani Liaquat galvanises support for Fight4Hope at the Walk of Hope Image: Tessallated Photography
Lions Clubs member supporting Wear A Hat Day with Flowers
Our Western Region secured £1m donation
Supporters of Stonger Together for Nicola at a Three Peaks Challenge






Brain Tumour Research – Registered Charity 1153487 (England and Wales) and SC046840 (Scotland). 19 Company Limited by Guarantee 08570737. Report of The Trustees and Accounts, Year Ended 30th June 2022
Braving the cold for our 10,000 Steps a Day in February Facebook Challenge A10,000StepsADaychallenger proudlydisplayshisdailytracker
Manager Charlie enjoys taking part in Wear A Hat Day with Flowers
Kev McIntosh and daughter Eva on a Walk of Hope
Fundraising
Hiver Castle Triathlon, Vanessa Fewell and team
Operations and Financial Review (continued)
Fundraising Practices
Recent years have been very challenging for many sectors of the economy and the charity sector in particular, as a result of austerity, Brexit uncertainty, new regulations, a health crisis and now a cost-of-living crisis.
We consider ourselves a leader in good fundraising practice and supporter care, ensuring our supporters are treated fairly and with respect, and we voluntarily subscribe to the Fundraising Regulator’s Code of Fundraising Practice. All members of the team are required to demonstrate an understanding of the Code and make a commitment to act in accordance with its principles when they join the Charity and throughout their employment with the Charity.

Supporter feedback is an important source of information about how our work impacts on supporters and members of the public, providing us with insight and lessons for future fundraising activities.



As a national charity, our fundraisers will occasionally encounter people who may be in vulnerable circumstances. We aim to be especially careful and sensitive when engaging with vulnerable people, including those affected by cancer. We are confident in the safeguarding measures we have in place, including a whistleblowing hotline, but it is an issue we take very seriously and regularly review our Safeguarding Policy.
Communicating with members of the public, in person, on the telephone, by email or through social media are vital ways to engage people in our work and raise funds. This work is only carried out by members of our team – to date, we have not employed any external organisations or professional fundraisers to fundraise on our behalf.
In the time period of this report, we are pleased to report that we received no complaints relating to our fundraising activities.
20 Brain Tumour Research –
Charity 1153487
Registered
(England and Wales) and SC046840 (Scotland). Company Limited by Guarantee 08570737. Report of The Trustees and Accounts, Year Ended 30th June 2022
Back (L to R): Sean Broderick, Steve-Lee Robinson, Alan Smith. Front (L to R): Paul Smith OBE and Karen Morling. Credit: Karen Morling
Marathon runner and supporter Ethan Thompson
Amelia and Alfie having fun with Wear A Hat Day
Future Plans
Our mission is to increase the UK investment to £35 million a year while fundraising to create a sustainable network of seven Brain Tumour Research Centres of Excellence across the UK. We are currently funding three Centres of Excellence; Imperial College London, Queen Mary University of London and the University of Plymouth. In July 2022, we announced plans to fund a new, fourth Brain Tumour Research Centre of Excellence. Applications are being invited from UK-based researchers and their teams who will play a pivotal role in helping us achieve our vision of finding a cure for all types of brain tumours. Brain Tumour Research will be investing an initial £2.5 million over five years in the new Centre. The review process, involving our SMAB, patient representatives and additional international experts, will happen over the closing months of 2022 with the announcement of our new Centre planned for March 2023.
Our research policies are also being updated, as part of a review of our grants’ terms and conditions. Research policies are designed to provide guidance and a framework to help the researchers that we fund to conduct research to the highest standard. We provide not just the finances but also other support to enable high-quality research to continue to be delivered at our Centres of Excellence. As such, and for example, we will be reviewing the funding provided to PhD students to ensure that we provide competitive, sector-matching studentship funding packages, which include the costs to support professional and career development allowing the researchers that we support to thrive and reach their full potential. In addition, we will be updating our research open access, and academic integrity guidelines.
We emerge from 2021/22 an even stronger organisation, having made investments to make it fit for the future; further building reserves to make the organisation more resilient against future challenges and strengthening the team. Indeed, we increased our research spend to record levels, added to the Leadership Team and grew reserves to the level that means we have now launched a call for a new Centre of Excellence.
Our philosophy is to try to deliver an exceptional supporter experience every time, whether online or in person. To deliver our growth strategy, we will continue to innovate and broaden our range of income streams. We will test and learn, applying our learnings to increase our reach and grow the market, increasing the fundraising for research into brain tumours in the UK.
In particular, we will be focusing on specific strategies to grow our regular-giving programme, whilst corporate partnerships and major donors still remain an opportunity for growth; initiatives will be led by our recently-appointed Director of Income Generation and Development. We will continue to work both with previously

supportive Trusts and Foundations and other charitable organisations to increase the number and value of partnerships we have in this space.
We will continue to collaborate with our Member and other charities to bring together patients, carers, activists, researchers and clinicians as appropriate to accelerate progress in the brain tumour research sector. Together we can reach a wider number and range of beneficiaries, signposting to specialist organisations as appropriate, thereby growing the market and fundraising capacity.
Having launched our 2019 manifesto Find a Cure, our campaigning will continue to lead the sector, and we will also continue to provide the on-going secretariat for the APPGBT, whilst also using our position on the Steering Group of TJBCM and elsewhere to influence MPs and the Government to understand the continuing need for increased investment in research and awareness of the issues of research funding inequalities. Our overall goal remains to grow the market for brain tumour funding to the levels of other cancers. Having recently recruited a Policy and Public Affairs Officer, we will continue to work with and develop our relationship with the devolved UK Governments.
Reserves Policy
We monitor and review the suitability of our reserves policy at least annually. During the last year, we have conducted a review and consider the policy introduced in 2021 to continue to be suitable and appropriate for the Charity.
It remains our priority to protect our committed research spend. To this end, we perform rolling forecasts to ensure that the Charity maintains the level of reserves required to protect against any unexpected deterioration in our income which cannot be mitigated by savings in expenditure. The target level of reserves at 30th June 2022 has been calculated at £1.4 million, as the mid-point within the range £1.2 million to £1.6 million. The reserves target is calculated by assuming a 25% reduction in forecast income offset by a forecast reduction in discretionary costs of approximately 10%. We ended the year with unrestricted reserves of £1.4 million, in line with the target.
Brain Tumour Research – Registered Charity 1153487 (England and Wales) and SC046840 (Scotland). 21 Company Limited by Guarantee 08570737. Report of The Trustees and Accounts, Year Ended 30th June 2022
Unrestricted reserves of £1.4m in line with target
The All-Party Parliamentary Group on Brain Tumours
Call for fourth Centre of Excellence launched
Operations and Financial Review (continued)
Principal Risks and Uncertainties
With the support of the Leadership Team, the Trustees continually review risks as they arise and satisfy themselves that the systems and controls are in place to manage them as appropriate and practicable. The risk management process relies on our judgement of the risk likelihood and impact, and developing and monitoring appropriate controls. We maintain a Risk Register of the principal risks faced by the Charity and a full annual review is an important component of our governance framework.
As a fundraising charity with strategic objectives to fund a network of experts in sustainable brain tumour research and grow the national investment in brain tumour research in order to find a cure, our principal risk is the need to protect and grow our income. To this end, we see our principal risks include our supporter relationships, our brand reputation, our people, the quality of research available to fund and our ability to fund this research.
To grow and maintain a sustainable income, we continue to invest in developing a broad and diverse portfolio of income streams. Having grown our team of skilled digital marketeers who have successfully helped us reach new and broader audiences last year, our priority this year has been to grow the Community Fundraising team across the UK, which has been a challenge in the current environment.
Our success would not have been achieved without the commitment and talent of the whole team. Against a challenging recruitment landscape, we continue to endeavour to attract new and complementary skills to the team to broaden the knowledge, skills and experience of the Charity whilst maintaining the passion for our goal of finding a cure for brain tumours.

Failure to deliver a satisfactory supporter journey risks losing a donor’s support and adversely impacting our ability to grow income. Although this risk grows along with the growing supporter base, we believe we effectively mitigate this risk by expanding the fundraising team under experienced leadership and embedding best-in-class supporter care and management.
Damage to our reputation and negative sentiment in the wider sector is a risk we take seriously, although we believe the close relationships we develop with our supporter base helps minimise this risk and alleviate the potential impact.
We are also aware of the continuing threat of cyberattacks and cyber fraud in particular. Whilst we believe we have appropriate insurance and proper and adequate controls in place, we have increased the frequency of staff training to ensure all staff are fully aware of the risks and the steps they can take to reduce the risks arising from human error.
More broadly, frequent full-team training and development sessions allied to our regular competency and objectives-based appraisal process seek to promote the right behaviours, deliver results and retain key staff. During the year, we conducted our third annual employee engagement survey. We were delighted that our overall score improved again, this time to 81% (from 76%) – indeed, the highest score the survey provider had across all its clients.
Early in 2022, we were assessed by Investors in People and were delighted to be awarded Silver accreditation at the first attempt. The awarding body commented: “This is an organisation that fully understands the importance of having engaged, fulfilled and happy staff who want to join, remain and perform at their best for the Charity.”
The appointment of our first HR Officer will assist in the consistent application of the learnings from these surveys and assessments –we aspire to achieve the Gold level when re-assessed in 2025.

22 Brain Tumour Research – Registered Charity 1153487 (England and Wales) and SC046840 (Scotland). Company Limited by Guarantee 08570737. Report of The Trustees and Accounts, Year Ended 30th June 2022
Team Development Day –
Employee engagement score improved to 81% (from 76% previously)
We continue to invest in developing a broad and diverse portfolio of income streams
Grant Monitoring
The work carried out at our three dedicated Research Centres and BRAIN UK is vital and monitored carefully to ensure our money is well spent. Indeed, we owe it to brain tumour patients, their families and our supporters. It is also a condition of our membership of the AMRC, who regularly audit members to ensure good practice of review, to guarantee that only the best quality research is funded.
Grant Making Policy
Our Research Centres submit an Annual Report including a request for further funding. The funds are granted and approved by the Trustees following the advice of the SMAB and recommendations of the Research Sub-Committee resulting from a comprehensive review of the Annual Report, research results to date, Centre visits and researcher interviews.



Every five years, each Centre of Excellence is asked to complete a more in-depth version of the Annual Review Process. Its report is sent out to International Peer Review, to a panel consisting of reviewers with a specific area of expertise related to the focus of the Centre, as well as members of the SMAB who also have relevant areas of expertise. Members of the International Peer Review Board accompany the Brain Tumour Research team on a visit to the Centre under review.
The review is an important stage for the Charity to review the Centre’s progress over the previous five years and consider its plans for the next five years. This provides the Charity with an independent, expert assessment of the Centre’s achievements and goals. It also provides an opportunity for the Centre to include new areas of research that have been indicated as potential routes to a cure for brain tumours, based on its discoveries in the preceding five years.
It remains our fundamental goal to develop a network of dedicated Centres of Brain Tumour Research Excellence in order to build research capacity, promote sustainability and the growth of brain tumour research in the UK, rather than the funding of individual short-term project grants. Indeed, this year, plans were made to launch a call for a new Centre, our fourth, and the competition went live on 1st July 2022.
Whilst it will always be our policy to grant the maximum amount of available funds to brain tumour research each year, it is clear from our discussions with our Centre lead scientists that it is necessary to balance current funding with sustainable levels for the future. Our strategy is for continued growth, rather than increased grant funding levels in the short term, while we continue to build reserves to provide security of future grant funding.
Brain Tumour Research – Registered Charity 1153487 (England and Wales) and SC046840 (Scotland), 23 Company Limited by Guarantee 08570737. Report of The Trustees and Accounts, Year Ended 30th June 2022
Operations and Financial Review (continued)
Financial Performance
The tough fundraising environment continued into 2021/22 exacerbated by the developing cost of living crisis in 2022, which we are beginning to experience at the time of writing.
This year, just as the early and effective switch to virtual events and the continuing commitment and passion of our loyal supporters helped the Charity to mitigate the immediate impact of lockdown last year, so 2022 brought further success. The return of our DIY fundraisers has taken this fundraising to new levels. Elsewhere, we have extended our Facebook fundraising offering and in 2021-22, we again raised over £1.5 million on this platform. In addition to birthday and other special occasion fundraisers, our own unique Facebook Challenges recruited many new supporters and raised over £1 million between them. Other income streams also performed consistently well. The development of a family of Wear A Hat Day events returned income to the levels prior to lockdown. Regular giving continues to grow to help provide a sustainable level of income that is vital for our longterm success – we will continue to invest in recruiting regular donors. Trusts and Foundations were a welcome source of support and we were delighted to receive over £50k from Lions Clubs International Foundation. Our Member Charities were also a great support, and their donations continue to support vital researchers. It is also pleasing to see that we are being remembered by increasing numbers of people in their wills and we have seen legacies steadily grow as an income source and reach new levels in 2021/22.
The Charity was determined to use the strengthening reserves position and increased surplus to increase research expenditure, and we were delighted to award a record level of research grants of over £2.7 million in the year, compared to £1.5 million in 2020/21.
Grants committed to Queen Mary University of London during the year amounted to over £1 million, to the University of Plymouth £835k, to Imperial College London £651k and to BRAIN UK £60k. In addition, we committed nearly £200k to support vital new initiatives in collaboration with the Tessa Jowell Brain Cancer Mission and brainstrust. Of the grants committed to date, a total of £1.2 million was paid during the year, with over £3 million remaining committed for future payments, of which nearly £2.2 million is payable within 12 months.

We are delighted with the progress we have achieved in our key charitable objective of campaigning and raising awareness over recent years. This year, we stepped up our activity, ensuring that the underfunding in brain tumour research remained at the forefront of the government’s healthcare agenda despite other issues of the day. In order to drive and maintain the national investment in brain tumour research and build on this success, we have strengthened the team and increased our spend in this area to over £1 million, compared to £787k in the prior year. A further £50k was expended on liaison with our Member Charities and other educational activities.
Our increased income was facilitated by our investment in digital marketing and social media, as well as the larger, more specialist team. Recruiting new supporters required increased advertising on key social media, most especially Facebook. Elsewhere, regular communication with our supporter base during a difficult time for all was successful in maintaining engagement, but increased our printing and distribution costs. Our increased spend on digital marketing has resulted in the Charity being caught up in a little-known VAT rule that requires UK organisations to account for VAT from non-UK suppliers. Thus, Brain Tumour Research was required to register for VAT in 2021 as we are now exceeding the VAT registration threshold. Sadly, this VAT is not recoverable by the Charity, thereby significantly increasing our costs.
Overall, the cost of generating funds during this period increased to £1,843k from £1,386k, a substantial increase but notably less than the rate of growth in income.
Pleasingly, the strong increase in income, allied to the continued shrewd and careful management of costs, allowed us to substantially increase our spend on sustainable brain tumour research and generate a substantial surplus of £1.4 million, increasing our unrestricted reserves to £1.4 million. We can now confidently commence sustainably funding further Research Centres in the UK –this cannot come soon enough!
The charts on the right illustrate our expenditure as a percentage of income in 2021/22 and prior year, with reserves available to invest in further Centres reducing slightly to 18.0% from 23.7% last year. Moreover, as a result of every pound we invest in early stage, pioneering research, our Centres have been able to access further funding from other providers, in one case, by three times, validating our unique approach and support.
Unrestricted reserves for future research £1.4m
Record value of research grants £2.7m
24 Brain
30th June 2022
Tumour Research – Registered Charity 1153487 (England and Wales) and SC046840 (Scotland). Company Limited by Guarantee 08570737. Report of The Trustees and Accounts, Year Ended
Imperial College Healthcare NHS Trust
£1m invested in campaigning and raising awareness
Just 7% spent on administration

Brain Tumour Research – Registered Charity 1153487 (England and Wales) and SC046840 (Scotland). 25 Company Limited by Guarantee 08570737. Report of The Trustees and Accounts, Year Ended 30th June 2022 39.3% 18.0% 22.3% 0.2% 0.6% 12.4% 7.1% Research Grants Campaigning and Raising Awareness Education Generating Funds Governance Administration Reserves Where your money goes year ending June 2022 Where your money goes 30.9% 23.7% 23.3% 0.3% 0.7% 13.2% 7.9% Research Grants Campaigning and Raising Awareness Education Generating Funds Governance Administration Reserves Where your money goes year ending June 2021
Operations and Financial Review (continued)
Going Concern
Management and the Trustees regularly review detailed forecasts of income, expenditure and cash flows, typically projecting forward 12 months or more. The assumptions underlying the budget and forecasts are challenged, varied and tested to establish the likelihood of a range of possible outcomes including reasonable cash flow sensitivities. The forecast performance is carefully monitored against actual outcomes each month and variances are highlighted, analysed and discussed at Management and Board level.
The Trustees have reviewed cash flow forecasts for the period to st December 2023 and considered cash flow requirements for this period for the purposes of approving these financial statements.
The cash flow forecasts indicate that the Charity will be able to pay its liabilities as they fall due for the period until at least 31st December 2023. In the event that income does not hit the projected levels, management is able to adjust discretionary expenditure to relieve any short-term cash pressures which might arise.
Given the previous experience of negative reserves, the Trustees have specified maintaining a minimum available cash balance of £500k, which we have consistently attained. Indeed, throughout the last 12 months, cash has exceeded £2 million and we finished the year with over £5 million. The Charity is now exploring suitable investments that will protect this cash from the ravages of inflation.

The Trustees are, therefore, satisfied that the financial statements should be prepared on the going concern basis and have advised Management to work on the basis of a continued growth strategy with initiatives and contingencies built in. Management also focus on building reserves that allow for sustainable research funding of our Centres and the growth of our network as we introduce new Centres, whilst also continuing to campaign for increased national investment in brain tumour research.
Trustees’ Responsibilities in Relation to the Financial Statements
The Trustees, who are also directors of the charitable company (for the purposes of company law) are responsible for preparing the Trustees’ Report and the financial statements in accordance with applicable law and United Kingdom Accounting Standards (United Kingdom Generally Accepted Accounting Practice).
Company law requires the Trustees to prepare financial statements for each financial year which give a true and fair view of the state of affairs of the charitable company and of the incoming resources and application of resources, including the income and expenditure, of the Charity for that period. In preparing these financial statements, the Trustees are required to:
• Select suitable accounting policies and then apply them consistently
• Observe the methods and principles of the Charities SORP FRS 102
• Make judgements and estimates that are reasonable and prudent
• State whether applicable accounting standards have been followed, subject to any material departures disclosed and explained in the financial statements
• Prepare the financial statements on the going concern basis unless it is inappropriate to presume that the charitable company will continue in business
The Trustees are responsible for keeping adequate accounting records that disclose with reasonable accuracy at any time the financial position of the charitable company and enable them to ensure that the financial statements comply with the Companies Act 2006. They are also responsible for safeguarding the assets of the charitable company and hence for taking reasonable steps for the prevention and detection of fraud and other irregularities.
26 Brain Tumour Research – Registered Charity 1153487 (England and Wales) and SC046840 (Scotland). Company Limited by Guarantee 08570737. Report of The Trustees and Accounts, Year Ended 30th June 2022
whilst continuing to campaign for increased national investment
Focus on building reserves that allow for sustainable research funding...
Derrick Evans MBE leading the Mr Motivator workout for brain tumours challenge
Statement of Disclosure to Auditors
Insofar as the Trustees are aware:
• There is no relevant audit information of which the charitable company’s auditor is unaware
• The Trustees have taken all steps that they ought to have taken to make themselves aware of any relevant audit information and to establish that the auditor is aware of that information

• The Trustees are responsible for the maintenance and integrity of the corporate and financial information included on the charitable company’s website. Legislation in the United Kingdom governing the preparation and dissemination of financial statements may differ from legislation in other jurisdictions

Approved by the Trustees on 25th January 2023 and signed on their behalf by


 Wendy Fulcher Chairman of the Trustees
Wendy Fulcher Chairman of the Trustees
Brain Tumour Research – Registered Charity 1153487 (England and Wales) and SC046840 (Scotland), 27 Company Limited by Guarantee 08570737. Report of The Trustees and Accounts, Year Ended 30th June 2021
Transplanted meningioma tissue. Image credit: the University of Plymouth
Philip Scard proudly places tiles at our Wall of Hope at Queen Mary University of London
Pupils at The Meadows Montessori Independent School enjoy Wear A Hat Day
Our supporters campaign to Stop the Devastation
Independent Auditor’s Report to the Trustees of Brain Tumour Research
Opinion
We have audited the financial statements of Brain Tumour Research (the ‘charitable company’) for the year ended 30th June 2022 which comprise the statement of financial activities, balance sheet, statement of cash flows and notes to the financial statements, including significant accounting policies. The financial reporting framework that has been applied in their preparation is applicable law and United Kingdom Accounting Standards, including FRS 102 The Financial Reporting Standard applicable in the UK and Republic of Ireland (United Kingdom Generally Accepted Accounting Practice).
In our opinion, the financial statements:
• Give a true and fair view of the state of the charitable company’s affairs as at 30th June 2022 and of its incoming resources and application of resources, including its income and expenditure, for the year then ended
• Have been properly prepared in accordance with United Kingdom Generally Accepted Accounting Practice
• Have been prepared in accordance with the requirements of the Companies Act 2006, the Charities and Trustee Investment (Scotland) Act 2005 and regulation 8 of the Charities Accounts (Scotland) Regulations 2006 (as amended)
Basis for Opinion
We conducted our audit in accordance with International Standards on Auditing (UK) (ISAs (UK)) and applicable law. Our responsibilities under those standards are further described in the Auditor’s responsibilities for the audit of the financial statements section of our report. We are independent of the charitable company in accordance with the ethical requirements that are relevant to our audit of the financial statements in the UK, including the FRC’s Ethical Standard and we have fulfilled our other ethical responsibilities in accordance with these requirements. We believe that the audit evidence we have obtained is sufficient and appropriate to provide a basis for our opinion.
Conclusions Relating to Going Concern
In auditing the financial statements, we have concluded that the Trustees’ use of the going concern basis of accounting in the preparation of the financial statements is appropriate.
Based on the work we have performed, we have not identified any material uncertainties relating to events or conditions that, individually or collectively, may cast significant doubt on Brain Tumour Research’s ability to continue as a going concern for a period of at least 12 months from when the financial statements are authorised for issue.
Our responsibilities and the responsibilities of the Trustees with respect to going concern are described in the relevant sections of this report.
Other Information
The other information comprises the information included in the Trustees’ Annual Report, other than the financial statements and our auditor’s report thereon. The Trustees are responsible for the other information contained within the Annual Report. Our opinion on the financial statements does not cover the other information and, except
to the extent otherwise explicitly stated in our report, we do not express any form of assurance conclusion thereon. Our responsibility is to read the other information and, in doing so, consider whether the other information is materially inconsistent with the financial statements or our knowledge obtained in the course of the audit, or otherwise appears to be materially misstated. If we identify such material inconsistencies or apparent material misstatements, we are required to determine whether this gives rise to a material misstatement in the financial statements themselves. If, based on the work we have performed, we conclude that there is a material misstatement of this other information, we are required to report that fact.
We have nothing to report in this regard.
Opinions on Other Matters Prescribed by the Companies Act 2006
In our opinion, based on the work undertaken in the course of the audit:
• The information given in the Trustees’ Annual Report for the financial year for which the financial statements are prepared is consistent with the financial statements
• The Trustees’ Annual Report has been prepared in accordance with applicable legal requirements
Matters on Which we are Required to Report by Exception
In the light of the knowledge and understanding of the charitable company and its environment obtained in the course of the audit, we have not identified material misstatements in the Trustees’ Annual Report. We have nothing to report in respect of the following matters in relation to which the Companies Act 2006 and the Charities Accounts (Scotland) Regulations 2006 (as amended) require us to report to you if, in our opinion:
• Adequate accounting records have not been kept, or returns adequate for our audit have not been received from branches not visited by us
• The financial statements are not in agreement with the accounting records and returns
• Certain disclosures of Trustees’ remuneration specified by law are not made
• We have not received all the information and explanations we require for our audit
• The Directors were not entitled to prepare the financial statements in accordance with the small companies’ regime and take advantage of the small companies’ exemptions in preparing the Trustees’ Annual Report and from the requirement to prepare a strategic report
Responsibilities of Trustees
As explained more fully in the statement of Trustees’ responsibilities set out in the Trustees’ Annual Report, the Trustees (who are also the Directors of the charitable company for the purposes of company law) are responsible for the preparation of the financial statements
28 Brain Tumour Research – Registered Charity 1153487 (England and Wales) and SC046840 (Scotland). Company Limited by Guarantee 08570737. Report of The Trustees and Accounts, Year Ended 30th June 2022
and for being satisfied that they give a true and fair view, and for such internal control as the Trustees determine is necessary to enable the preparation of financial statements that are free from material misstatement, whether due to fraud or error.
In preparing the financial statements, the Trustees are responsible for assessing the charitable company’s ability to continue as a going concern, disclosing, as applicable, matters related to going concern and using the going concern basis of accounting unless the Trustees either intend to liquidate the charitable company or to cease operations, or have no realistic alternative but to do so.
Auditor’s Responsibilities for the Audit of the Financial Statements
We have been appointed as auditor under section 44(1)(c) of the Charities and Trustee Investment (Scotland) Act 2005 and under the Companies Act 2006 and report in accordance with regulations made under those Acts.
Our objectives are to obtain reasonable assurance about whether the financial statements as a whole are free from material misstatement, whether due to fraud or error, and to issue an auditor’s report that includes our opinion. Reasonable assurance is a high level of assurance but is not a guarantee that an audit conducted in accordance with ISAs (UK) will always detect a material misstatement when it exists. Misstatements can arise from fraud or error and are considered material if, individually or in the aggregate, they could reasonably be expected to influence the economic decisions of users taken on the basis of these financial statements.
Irregularities, including fraud, are instances of non-compliance with laws and regulations. We design procedures in line with our responsibilities, outlined above, to detect material misstatements in respect of irregularities, including fraud. The extent to which our procedures are capable of detecting irregularities, including fraud are set out below.
Capability of the Audit in Detecting Irregularities
In identifying and assessing risks of material misstatement in respect of irregularities, including fraud and non-compliance with laws and regulations, our procedures included the following:
• We enquired of management, which included obtaining and reviewing supporting documentation, concerning the charity’s policies and procedures relating to:
identifying, evaluating, and complying with laws and regulations and whether they were aware of any instances of non-compliance
detecting and responding to the risks of fraud and whether they have knowledge of any actual, suspected, or alleged fraud
- the internal controls established to mitigate risks related to fraud or non-compliance with laws and regulations
• We inspected the minutes of meetings of those charged with governance
• We obtained an understanding of the legal and regulatory framework that the Charity operates in, focusing on those laws
and regulations that had a material effect on the financial statements or that had a fundamental effect on the operations of the Charity from our professional and sector experience
• We communicated applicable laws and regulations throughout the audit team and remained alert to any indications of noncompliance throughout the audit
• We reviewed any reports made to regulators
• We reviewed the financial statement disclosures and tested these to supporting documentation to assess compliance with applicable laws and regulations
• We performed analytical procedures to identify any unusual or unexpected relationships that may indicate risks of material misstatement due to fraud
• In addressing the risk of fraud through management override of controls, we tested the appropriateness of journal entries and other adjustments, assessed whether the judgements made in making accounting estimates are indicative of a potential bias and tested significant transactions that are unusual or those outside the normal course of business
Because of the inherent limitations of an audit, there is a risk that we will not detect all irregularities, including those leading to a material misstatement in the financial statements or non-compliance with regulation. This risk increases the more that compliance with a law or regulation is removed from the events and transactions reflected in the financial statements, as we will be less likely to become aware of instances of non-compliance. The risk is also greater regarding irregularities occurring due to fraud rather than error, as fraud involves intentional concealment, forgery, collusion, omission or misrepresentation.
A further description of our responsibilities is available on the Financial Reporting Council’s website at: www.frc.org.uk/auditorsresponsibilities This description forms part of our auditor’s report.
Use of our Report
This report is made solely to the charitable company’s members as a body, in accordance with Chapter 3 of Part 16 of the Companies Act 2006 and section 44(1)(c) of the Charities and Trustee Investment (Scotland) Act 2005. Our audit work has been undertaken so that we might state to the charitable company’s members those matters we are required to state to them in an auditor’s report and for no other purpose. To the fullest extent permitted by law, we do not accept or assume responsibility to anyone other than the charitable company and the charitable company’s members as a body, for our audit work, for this report, or for the opinions we have formed.
Noelia Serrano (Senior statutory auditor)
23rd February 2023
for and on behalf of Sayer Vincent LLP, Statutory Auditor Invicta House, 108-114 Golden Lane, LONDON, EC1Y 0TL Sayer Vincent LLP is eligible to act as auditor in terms of section 1212 of the Companies Act 2006

Brain Tumour Research – Registered Charity 1153487 (England and Wales) and SC046840 (Scotland). 29 Company Limited by Guarantee 08570737. Report of The Trustees and Accounts, Year Ended 30th June 2022
–
–
Statement of Financial Activities
All of the above results are derived from continuing activities. There were no other recognised gains or losses other than those stated above. Movements in funds are disclosed in Note 19 to the financial statements. The notes on pages 34 to 42 form part of these financial statements.
30 Brain Tumour Research – Registered Charity 1153487 (England and Wales) and SC046840 (Scotland). Company Limited by Guarantee 08570737. Report of The Trustees and Accounts, Year Ended 30th June 2022
Note 2022 Unrestricted £ 2022 Restricted £ 2022 Total £ 2021 Unrestricted £ 2021 Restricted £ 2021 Total £ Income from: Donations and legacies 2 4,782,961 1,602,942 6,385,903 4,177,792 345,657 4,523,449 Other trading activities 3 1,144,600 – 1,144,600 791,122 – 791,122 TOTAL INCOME 5,927,561 1,602,942 7,530,503 4,968,914 345,657 5,314,571 Expenditure on: Raising funds 4 1,842,809 – 1,842,809 1,385,797 – 1,385,797 Charitable activities: Research grants 4 2,527,945 724,609 3,252,554 1,512,443 327,324 1,839,767 Campaigning and raising awareness 4 1,027,483 – 1,027,483 786,688 – 786,688 Members liaison, workshop and conferences 4 49,709 – 49,709 44,097 – 44,097 TOTAL EXPENDITURE 5,447,946 724,609 6,172,555 3,729,025 327,324 4,056,349 Net income before net gains on investments 479,615 878,333 1,357,948 1,239,889 18,333 1,258,222 Net (loss)/gain on investments 12 (88) – (88) 67 – 67 Net income for the year and net movement in funds 6 479,527 878,333 1,357,860 1,239,956 18,333 1,258,289 Reconciliation of funds: Total funds brought forward 931,557 168,333 1,099,890 (308,399) 150,000 (158,399) TOTAL FUNDS CARRIED FORWARD 1,411,084 1,046,666 2,457,750 931,557 168,333 1,099,890
Balance Sheet

Brain Tumour Research – Registered Charity 1153487 (England and Wales) and SC046840 (Scotland). 31 Company Limited by Guarantee 08570737. Report of The Trustees and Accounts, Year Ended 30th June 2022
Note 2022 £ 2022 £ 2021 £ 2021 £ Fixed assets: Tangible assets 11 52,640 33,414 Investments 12 96 184 52,736 33,598 Current assets: Stock 13 40,515 58,390 Debtors 14 301,213 304,955 Debtors recoverable in more than one year 15 19,499 36,362 Cash at bank and in hand 21 5,344,217 2,360,973 5,705,444 2,760,680 Liabilities: Creditors: amounts falling due within one year 16 (2,428,980) (1,248,590) Net current assets 3,276,464 1,512,090 Total assets less current liabilities 3,329,200 1,545,688 Creditors: amounts falling due after one year 17 (871,450) (445,798) TOTAL NET ASSETS 18 2,457,750 1,099,890 The funds of the Charity: 19a Restricted income funds 1,046,666 168,333 Unrestricted income funds: General funds 1,411,084 931,557 Total unrestricted funds 1,411,084 931,557 TOTAL FUNDS 2,457,750 1,099,890 Approved by the Trustees on 25th January 2023 and signed on their behalf by:
Wendy Fulcher Chairman of Trustees
Sukanta Ghosh Trustee
Statement of Cash Flows
32 Brain Tumour Research – Registered Charity 1153487 (England and Wales) and SC046840 (Scotland). Company Limited by Guarantee 08570737. Report of The Trustees and Accounts, Year Ended 30th June 2022
Note £ 2021 £ £ 2020 £ Cash flows from operating activities: Net cash provided by operating activities 20 3,029,404 1,787,512 Cash flows from investing activities: Purchase of fixed assets (46,160) (12,610) Net cash (used in) investing activities (46,160) (12,610) Change in cash and cash equivalents in the year 2,983,244 1,774,902 Cash and cash equivalents at the beginning of the year 2,360,973 586,071 CASH AND CASH EQUIVALENTS AT THE END OF THE YEAR 21 5,344,217 2,360,973
Notes to the Financial Statements
1 Accounting policies
1.1 Statement of compliance
The financial statements have been prepared in accordance with Accounting and Reporting by Charities: Statement of Recommended Practice applicable to charities preparing their accounts in accordance with the Financial Reporting Standard applicable in the UK and Republic of Ireland (FRS 102) – (Charities SORP FRS 102), the Financial Reporting Standard applicable in the UK and Republic of Ireland and the Companies Act 2006.
Brain Tumour Research is a charitable company limited by guarantee and is incorporated in the United Kingdom. The registered office address and principal place of business, is Suite 37, Shenley Pavilions, Chalkdell Drive, Shenley Wood, Milton Keynes, MK5 6LB.
All figures are presented in sterling and rounded to the nearest pound.
1.2 Basis of preparation
In applying the financial reporting framework, the Trustees have made a number of subjective judgements, for example in respect of significant accounting estimates. Estimates and judgements are continually evaluated and are based on historical experience and other factors, including expectations of future events that are believed to be reasonable under the circumstances. The nature of the estimation means the actual outcomes could differ from those estimates. Any significant estimates and judgements affecting these financial statements are detailed within the relevant accounting policy below.
1.3 Public benefit entity
The charitable company meets the definition of a public benefit entity under FRS 102.
1.4 Going concern
The Charity’s charitable and fundraising activities, along with the operating environment, performance and prospects are set out on pages 10 to 27 in the body of the Annual Report. Management and the Trustees regularly review detailed forecasts of income, expenditure and cash flows, regularly projecting forward 12 months or more. The assumptions underlying the budget and forecasts are challenged, varied and tested to establish the likelihood of a range of possible outcomes including reasonable cash flow sensitivities. The expected figures are carefully monitored against actual outcomes each month and variances are highlighted, analysed and discussed at Management and Board level.
The Trustees have reviewed cash flow forecasts for the period to 31st December 2023 and considered cash flow requirements for the period to 31st December 2023 for the purposes of approving these financial statements.
The cash flow forecasts indicate that the Charity will be able to pay its debts as they fall due for the period until at least 31st December 2023. In the event that income does not hit the projected levels, management is able to adjust discretionary expenditure to relieve any short term cash pressures which might arise. The trustees have specified maintaining a minimum cash balance of £500k. Management will monitor income and expenditure and ensure that payments are managed to achieve this level.
The Trustees are, therefore, satisfied that the financial statements should be prepared on the going concern basis.
1.5 Income
Income is recognised when the Charity has entitlement to the funds, any performance conditions attached to the income have been met, it is probable that the income will be received and that the amount can be measured reliably.
Income from grants is recognised when the Charity has entitlement to the funds, any performance conditions attached to the grants have been met, it is probable that the income will be received and the amount can be measured reliably and is not deferred.
For legacies, entitlement is taken as the earlier of the date on which either: the Charity is aware that probate has been granted, the estate has been finalised and notification has been made by the executor(s) to the charity that a distribution will be made, or when a distribution is received from the estate. Receipt of a legacy, in whole or in part, is only considered probable when the amount can be measured reliably and the charity has been notified of the executor’s intention to make a distribution. Where legacies have been notified to the Charity, or the Charity is aware of the granting of probate, and the criteria for income recognition have not been met, then the legacy is treated as a contingent asset and disclosed if material.
Income received in advance of the provision of a specified service is deferred until the criteria for income recognition are met.
1.6 Donations of gifts, services and facilities
Donated professional services and donated facilities are recognised as income when the charity has control over the item or received the service, any conditions associated with the donation have been met, the receipt of economic benefit from the use by the Charity of the item is probable and that economic benefit can be measured reliably. In accordance with the Charities SORP (FRS 102), volunteer time is not recognised so please refer to the trustees’ Annual Report for more information about their contribution.
On receipt, donated gifts, professional services and donated facilities are recognised on the basis of the value of the gift to the charity which is the amount the Charity would have been willing to pay to obtain services or facilities of equivalent economic benefit on the open market; a corresponding amount is then recognised in expenditure in the period of receipt.
Brain Tumour Research – Registered Charity 1153487 (England and Wales) and SC046840 (Scotland). 33 Company Limited by Guarantee 08570737. Report of The Trustees and Accounts, Year Ended 30th June 2022
Notes to the Financial Statements
1.7 Interest receivable
Interest on funds held on deposit is included when receivable and the amount can be measured reliably by the Charity; this is normally upon notification of the interest paid or payable by the bank.
1.8 Fund accounting
Restricted funds are to be used for specific purposes as laid down by the donor. Expenditure which meets these criteria is charged to the fund.
Unrestricted funds are donations and other incoming resources received or generated for the charitable purposes.
Designated funds are unrestricted funds earmarked by the Trustees for particular purposes.
1.9 Expenditure and irrecoverable VAT
Expenditure is recognised once there is a legal or constructive obligation to make a payment to a third party, it is probable that settlement will be required and the amount of the obligation can be measured reliably. Expenditure is classified under the following activity headings:
•Costs of raising funds relate to the costs incurred by the charity in inducing third parties to make voluntary contributions to it, as well as the cost of any activities with a fundraising purpose
•Expenditure on charitable activities includes the costs of grants made to research institutions, lobbying and PR activities and other educational activities undertaken to further the purposes of the charity and their associated support costs
Irrecoverable VAT is charged as a cost against the activity for which the expenditure was incurred.
1.10 Allocation of support costs
Resources expended are allocated to the particular activity where the cost relates directly to that activity. However, the cost of overall direction and administration of each activity, comprising the salary and overhead costs of the central function, is apportioned on the basis set out in note 4. Governance costs are the costs associated with the governance arrangements of the Charity. These costs are associated with constitutional and statutory requirements and include any costs associated with the strategic management of the Charity’s activities.
1.11 Operating leases
Rental charges are charged on a straight line basis over the term of the lease.
1.12 Tangible fixed assets
Items of equipment are generally capitalised where the purchase price exceeds £250. Depreciation costs are allocated to activities on the basis of the use of the related assets in those activities. Assets are reviewed for impairment if circumstances indicate their carrying value may exceed their net realisable value and value in use.
Fixed assets include the office telephone system, laptops, PCs, software, furniture and Wall of Hope panels. Where fixed assets have been revalued, any excess between the revalued amount and the historic cost of the asset will be shown as a revaluation reserve in the balance sheet.
Depreciation is provided at rates calculated to write down the cost of each asset to its estimated residual value over its expected useful life. The depreciation rates in use are as follows:
1.13 Listed investments
Investments are a form of basic financial instrument and are initially recognised at their transaction value and subsequently measured at their fair value as at the balance sheet date using the closing quoted market price. Any change in fair value will be recognised in the statement of financial activities and any excess of fair value over the historic cost of the investments will be shown as a fair value reserve in the balance sheet. Investment gains and losses, whether realised or unrealised, are combined and shown in the heading “Net gains/(losses) on investments” in the statement of financial activities. The charity does not acquire put options, derivatives or other complex financial instruments.
1.14 Stocks
Stocks are stated at the lower of cost and net realisable value. In general, cost is determined on a first in first out basis and includes transport and handling costs. Net realisable value is the price at which stocks can be sold in the normal course of business after allowing for the costs of realisation. Provision is made where necessary for obsolete, slow moving and defective stocks. Donated items of stock, held for distribution or resale, are recognised at fair value which is the amount the charity would have been willing to pay for the items on the open market.
1.15 Trade and other debtors
Trade and other debtors are recognised at the settlement amount due after any trade discount offered. Prepayments are valued at the amount prepaid net of any trade discounts due.
34 Brain Tumour Research – Registered Charity 1153487 (England and Wales) and SC046840 (Scotland). Company Limited by Guarantee 08570737. Report of The Trustees and Accounts, Year Ended 30th June 2022
Computer equipment 3-5 years Fixtures and fittings 5 years Leasehold improvements Remaining length of the lease at time of investment
1.16 Cash at bank and in hand
Cash at bank and cash in hand includes cash and short term highly liquid investments with a short maturity of three months or less from the date of acquisition or opening of the deposit or similar account.
1.17 Creditors and provisions
Creditors and provisions are recognised where the Charity has a present obligation resulting from a past event that will probably result in the transfer of funds to a third party and the amount due to settle the obligation can be measured or estimated reliably. Creditors and provisions are normally recognised at their settlement amount after allowing for any trade discounts due. A provision is used when there is uncertainty over the amount or timing of the liability.
2 Income from donations and legacies
1.18 Financial instruments
The Charity only has financial assets and financial liabilities of a kind that qualify as basic financial instruments. Basic financial instruments are initially recognised at transaction value and subsequently measured at their settlement value.
1.19
Pensions
The charitable company operates two defined contributions pension schemes. The schemes are funded partly by contributions from the employees and from the Charity. Such contributions are held and administered completely independent of the charitable company’s finances. The contributions are made by the Charity and are accounted for on an accruals basis.
1.20 Trustees remuneration
All Trustees donate their time spent running the Charity on a voluntary basis and do not receive remuneration for their work, but are entitled to reimbursement for any expenses incurred in carrying out their duties.
* Fundraising Groups are supporter groups who organise events and other activities to raise money on behalf of and under the umbrella of Brain Tumour Research.
3 Income from other trading activities
Brain Tumour Research – Registered Charity 1153487 (England and Wales) and SC046840 (Scotland). 35 Company Limited by Guarantee 08570737. Report of The Trustees and Accounts, Year Ended 30th June 2022
2022 Unrestricted £ 2022 Restricted £ 2022 Total £ 2021 Unrestricted £ 2021 Restricted £ 2021 Total £ Fundraising 3,189,842 – 3,189,842 3,086,842 – 3,086,842 Individual donations 516,396 1,070,400 1,586,796 444,018 38,140 482,158 Memorial donations 459,032 – 459,032 353,917 – 353,917 Donations from Fundraising Groups* 176,838 – 176,838 92,592 – 92,592 Trusts 155,542 205,702 361,244 98,103 307,517 405,620 Legacies 273,441 – 273,441 75,420 – 75,420 Corona Virus Job Retention Scheme – – – 21,385 – 21,385 Corona Virus Research Grant – 326,840 326,840 – – –Donor Marketing 11,870 – 11,870 5,516 – 5,516 TOTALS 4,782,961 1,602,942 6,385,903 4,177,792 345,657 4,523,449
2022 Unrestricted £ 2022 Restricted £ 2022 Total £ 2021 Unrestricted £ 2021 Restricted £ 2021 Total £ Challenge events 819,762 – 819,762 406,789 – 406,789 Campaigns 243,308 – 243,308 300,324 – 300,324 Merchandise 55,282 – 55,282 56,261 – 56,261 Online fundraising 26,248 – 26,248 27,748 – 27,748 TOTALS 1,144,600 – 1,144,600 791,122 – 791,122
Notes to the Financial Statements (continued)
4a Analysis of expenditure
Support and governance costs have been apportioned based on estimated usage as a proportion of directly attributable expenditure.
36 Brain Tumour Research – Registered Charity 1153487 (England and Wales) and SC046840 (Scotland). Company Limited by Guarantee 08570737. Report of The Trustees and Accounts, Year Ended 30th June 2022
Charitable activities Note Cost of raising funds £ Research £ Campaigning and raising awareness £ Members liaison, workshop and conferences £ 2022 Total £ 2021 Total £ Staff Costs: 7 725,854 204,293 548,333 44,766 1,523,245 1,117,964 Direct Costs: Research grants committed 5 – 2,722,436 – – 2,722,436 1,495,390 Social media 286,055 – 130,310 – 416,365 224,158 Challenge events 126,336 – – – 126,336 195,471 Fundraising and other agency commission 108,385 – – – 108,385 76,485 Digital marketing 43,532 – 43,532 – 87,064 11,490 Printing 46,236 234 35,592 – 82,063 48,121 Artwork and design 48,384 120 30,769 510 79,783 64,577 Advertising 55,861 – 20,681 – 76,542 103,170 Other direct costs 237,816 35,395 126,631 – 399,842 284,841 952,605 2,758,185 387,515 510 4,098,815 2,503,703 Support Costs: Property costs 44,508 78,556 24,816 1,201 149,080 132,114 Accounting, consulting and contractors fees 27,890 49,226 15,551 752 93,419 101,339 HR and Recruitment 19,046 33,615 10,619 514 63,794 17,404 Depreciation 8,041 14,193 4,483 217 26,934 28,625 Training and development 9,320 16,449 5,196 251 31,217 380 Sundry other costs 51,270 90,491 28,586 1,383 171,731 140,985 160,074 282,530 89,251 4,318 536,174 420,847 Governance Costs: Audit fee 3,657 6,455 2,039 99 12,250 13,800 Companies House and other fees 618 1,091 345 17 2,071 35 4,276 7,546 2,384 115 14,321 13,835 Total expenditure 2022 1,842,809 3,252,554 1,027,483 49,709 6,172,555 4,056,349 Total expenditure 2021 1,385,797 1,839,767 786,688 44,097 4,056,349
4b Analysis of expenditure Charitable activities
Support and governance costs have been apportioned based on estimated usage as a proportion of directly attributable expenditure.
Brain Tumour Research – Registered Charity 1153487 (England and Wales) and SC046840 (Scotland). 37 Company Limited by Guarantee 08570737. Report of The Trustees and Accounts, Year Ended 30th June 2022
Note Cost of raising funds £ Research £ Campaigning and raising awareness £ Members liaison, workshop and conferences £ 2021 Total £ Staff costs: 7 522,888 147,226 411,550 36,299 1,117,964 Direct costs: Research grants committed 5 – 1,495,390 – – 1,495,390 Social Media 144,806 – 79,352 – 224,158 Challenge events 195,471 – – – 195,471 Advertising 54,878 – 48,293 – 103,170 Fundraising and other agency commisson 76,485 – – – 76,485 Artwork and design 38,746 – 25,831 – 64,577 Printing 34,695 – 13,426 – 48,121 Other direct costs 169,324 – 123,934 3,073 296,331 714,405 1,495,390 290,835 3,073 2,503,703 Support Costs: Property costs 45,135 59,921 25,622 1,436 132,114 Accounting, consulting and contractors fees 34,621 45,963 19,654 1,102 101,339 Depreciation 9,779 12,983 5,551 311 28,625 Training and development 130 172 74 4 380 Sundry other costs 54,112 71,838 30,718 1,722 158,389 143,777 190,876 81,619 4,575 420,847 Governance Costs: Audit fee 4,715 6,259 2,676 150 13,800 Companies House and other fees 12 16 7 – 35 4,727 6,275 2,683 150 13,835 Total expenditure 2021 1,385,797 1,839,767 786,688 44,097 4,056,349
Notes to the Financial Statements (continued)
5 Grants payable
committed in the year and the grant commitment carried forward at 30th June 2022 comprised:
6 Net income for the year
This is stated after charging:
38 Brain Tumour Research – Registered Charity 1153487 (England and Wales) and SC046840 (Scotland). Company Limited by Guarantee 08570737. Report of The Trustees and Accounts, Year Ended 30th June 2022
2022 £ 2021 £ Grant commitment brought forward 1,502,419 970,034 Grants committed in the year 2,722,436 1,508,654 Grants withdrawn in the year – (13,264) Grants paid (1,183,966) (963,005) Grant commitment carried forward 3,040,889 1,502,419
2022 £ 2021 £ Depreciation 26,934 28,625 Loss on disposal of fixed assets – –Operating lease rentals: Property 90,241 81,638 Auditors’ remuneration
Audit 9,975 9,500
Grants committed brought forward £ Grants committed in the year £ Prior year grants withdrawn in the year £ Grants paid Grants committed carried forward £ Payable within one year £ Payable after one year £ University of Plymouth 364,687 835,244 – (347,502) 852,429 675,535 176,894 Queen Mary University London 677,095 1,005,905 – (520,446) 1,162,554 743,062 419,492 Imperial College London 416,389 650,620 – (253,777) 813,232 550,093 263,139 University of Southampton 44,248 60,000 – (52,241) 52,007 52,007 –brainstrust – 40,000 – (10,000) 30,000 30,000 –Tessa Jowell Brain Cancer Mission CIC – 130,667 – – 130,667 130,667 –1,502,419 2,722,436 – (1,183,966) 3,040,889 2,181,364 859,525
(excluding VAT):
Grants
7 Analysis of staff costs, Trustee remuneration and expenses, and the cost of key management personnel
Staff costs were as follows:
The following number of employees recieved employee benefits (excluding employer pension costs and employers’ national insurance) during the year between:
The total employee benefits including pension contributions and employer’s national insurance of the key management personnel were
The Charity Trustees were not paid and did not receive any other benefits from employment with the charity in the year (2021: £nil). No Trustee received reimbursement of expenses incurred during the year (2021: £nil).
8 Staff numbers
The average number of employees (headcount based on number of staff employed) during the year was as follows:
9 Related party transactions
There were no related party transactions in the year ended June 2022. In the year ended June 2021, the Charity spent £5,283 with Wendy O’Brien (a sister of the Chief Executive) on telemarketing and database building services.
10 Taxation
There are no donations from related parties which are outside the normal course of business and no restricted donations from related parties.
The Charity is exempt from corporation tax as the majority of its income is charitable and is applied for charitable purposes. Non-charitable income in the Charity is within the allowable limits.
Brain Tumour Research – Registered Charity 1153487 (England and Wales) and SC046840 (Scotland). 39 Company Limited by Guarantee 08570737. Report of The Trustees and Accounts, Year Ended 30th June 2022
2021 £ 2020 £ Salaries and wages 1,340,583 986,772 Recognition payment 10,711 9,044 Redundancy payment 10,167 –Redundancy provision (10,000) (7,064) Social security costs 135,902 99,084 Employer’s contribution to defined contribution pension schemes 35,881 30,128 1,523,245 1,117,964
2022 No. 2021 No. £60,000 - £69,999 3 2
£319,122 (2021: £177,442).
2022 No. 2021 No. Costs of generating funds 21.2 15.0 Research grants 4.0 3.3 Campaigning and raising awareness 13.7 10.1 Members liaison, workshop & conferences 0.9 0.8 39.8 29.2
2022 £ 2021 £
– 5,283
Notes to the Financial Statements (continued)
11 Tangible fixed assets
12 Listed investments
Investments are revalued at market value at the balance sheet date and any unrealised gain or loss is taken to the Statement of Financial Activities. Investments are intended to be available at short notice for use by the Charity in its charitable activities.
Stock comprises merchandise for resale such as running vests, cycling jerseys, caps, t-shirts, brooches and Christmas cards.
40 Brain Tumour Research – Registered Charity 1153487 (England and Wales) and SC046840 (Scotland). Company Limited by Guarantee 08570737. Report of The Trustees and Accounts, Year Ended 30th June 2022
Computer equipment £ Fixtures and fittings £ Leasehold improvements £ Total £ Cost or valuation At the start of the year 83,529 58,353 10,692 152,575 Additions in year 31,271 7,594 7,296 46,160 Disposals in year – – – –At the end of the year 114,800 65,947 17,988 198,735 Depreciation At the start of the year 63,024 53,343 2,794 119,161 Charge for the year 19,194 4,121 3,619 26,934 Eliminated on disposal – – – –At the end of the year 82,218 57,464 6,413 146,095 Net book value At the end of the year 32,582 8,483 11,575 52,640 At the start of the year 20,505 5,010 7,898 33,414 All of the above assets are used for charitable purposes.
2022 £ 2021 £ Fair value at the start of the year 184 117 Additions at cost – –Disposal proceeds – –Net (loss)/gain on change in fair value (88) 67 Fair value at the end of the year 96 184 Investments comprise: UK Equities – 1,607 ordinary shares in Bonhill Group PLC 96 184 96 184 13 Stock 2022 £ 2021 £ Merchandise and fundraising materials 40,515 58,390 40,515 58,390
14 Debtors
15 Debtors: amounts recoverable in more than one year
16 Creditors: amounts falling due within one year
17 Creditors: amounts falling due after one year
Brain Tumour Research – Registered Charity 1153487 (England and Wales) and SC046840 (Scotland). 41 Company Limited by Guarantee 08570737. Report of The Trustees and Accounts, Year Ended 30th June 2022
2022 £ 2021 £ Debtors represent
in
of
Fundraising platforms 113,572 134,867 Prepayments 187,641 170,088 301,213 304,955
amounts
respect
other debtors:
2022 £ 2021 £ Rent deposit 19,499 17,362 Places booked for events due to take place in more than one year – 19,000 19,499 36,362
2022 £ 2021 £ Grant commitments 2,181,364 1,063,420 Accruals and other creditors 247,616 185,170 2,428,980 1,248,590
2022 £ 2021 £ Creditors falling due in 1-2 years 541,016 211,588 Creditors falling due in 2-5 years 330,434 234,210 Creditors falling due in more than 5 years ––871,450 445,798
Notes to the Financial Statements (continued)
18a Analysis of net assets between funds (current year)
18b Analysis of net assets between funds (prior year)
42 Brain Tumour Research – Registered Charity 1153487 (England and Wales) and SC046840 (Scotland). Company Limited by Guarantee 08570737. Report of The Trustees and Accounts, Year Ended 30th June 2022
General unrestricted £ Designated £ Restricted £ 2022 Total funds £ 2021 Total funds £ Tangible fixed assets 52,640 – – 52,640 33,414 Investments 96 – – 96 184 Other net current assets 2,229,798 – 1,046,666 3,276,464 1,512,090 Long term liabilities (871,450) – – (871,450) (445,798) Net assets at the end of the year 1,411,084 – 1,046,666 2,457,750 1,099,890
General unrestricted £ Designated £ Restricted £ 2021 Total funds £ 2020 Total funds £ Tangible fixed assets 33,414 – – 33,414 49,430 Investments 184 – – 184 117 Other net current assets / (liabilities) 1,343,757 – 168,333 1,512,090 (206,246) Long term liabilities (445,798) – – (445,798) (1,700) Net assets at the end of the year 931,557 – 168,333 1,099,890 (158,399)
19a Movements in funds (current year)
Purposes of restricted funds
1. The grant from Ollie’s Fund was made with the express direction to fund Dr Sarah Badodi, Postdoctoral Research Fellow at the Queen Mary University of London over a period of five years.
2. The grant from The Garfield Weston Foundation was made with the express direction to fund research into Glioblastoma Multiforme (at Queen Mary University of London).
3. The grant from The Danny Green Fund was made with the express direction to fund research at the Queen Mary University of London.
4. The grant from In Sue’s Name was made with the express direction to fund a PhD researcher at the Queen Mary University of London.
5. The grant from In Sue’s Name was made with the express direction to fund research at the Queen Mary University of London.
6. The grant from James Clifford Campling Trust was made with the express direction to fund research into Glioblastoma Multiforme (at Queen Mary University of London).
7. The donation from an anonymous donor was made with the direction to fund research at a new Research Centre yet to be established.
8. The grant from the Brain Tumour Research Bright Club members was made with the express direction to fund a clinical research fellow at Imperial College London.
9. The grant from Shay’s Smiles was made with the express direction to fund a PhD researcher at the Queen Mary University of London.
10. The grant from The Bryan Guinness Charitable Trust was made with the direction to fund research at the Queen Mary University of London.
11. The grant from The William Low Trust was made with the express direction to fund a PhD researcher at the Queen Mary University of London.
12. The grant from Lions Clubs International of the British Isles was made with the express direction to fund research.
13. The grant from Lions Clubs International of the British Isles was made with the express direction to fund research equipment at University of Plymouth.
14. The grant from the Melvin Family was made to fund imaging equipment at the Queen Mary University of London.
15. The grant from UK Research and Innovation was made to support early career researchers in the UK
Brain Tumour Research – Registered Charity 1153487 (England and Wales) and SC046840 (Scotland). 43 Company Limited by Guarantee 08570737. Report of The Trustees and Accounts, Year Ended 30th June 2022
At the start of the year £ Income and gains £ Expenditure and losses £ Transfers £ At the end of the year £ Restricted funds: 1. Ollie’s Fund 75,000 – (75,000) – –2. Garfield Weston 93,333 – (46,667) – 46,666 3. The Danny Green Fund – 2,740 (2,740) – –4. In Sue’s Name – 36,037 (36,037) – –5. In Sue’s Name – 53,963 (53,963) – ––6. James Clifford Campling Trust – 1,000 (1,000) –7. Anonymous donor – 1,000,000 – – 1,000,000 8. Bright Clubt – 40,400 (40,400) – –9. Shay’s Smiles – 37,016 (37,016) – –10. The Bryan Guinness Charitable Trust – 1,000 (1,000) – –11. The William Low Trust – 20,000 (20,000) – –12. Lions Clubs International – 50,000 (50,000) – –13. Lions Clubs International – 3,946 (3,946) – –14. The Family of Ria Melvin – 30,000 (30,000) – –15. UK Research and Innovation – 326,840 (326,840) – –Total restricted funds 168,333 1,602,942 (724,609) – 1,046,666 General funds 931,557 5,927,473 (5,447,946) – 1,411,085 Total unrestricted funds 931,557 5,927,473 (5,447,946) – 1,411,085 Total funds 1,099,890 7,530,415 (6,172,555) – 2,457,751
Notes to the Financial Statements (continued)
19b Movements in funds (prior year)
Purposes of restricted funds
1. The grant from The Danny Green Fund was made with the express direction to fund research at the Queen Mary University of London.
2. The grant from In Sue’s Name was made with the express direction to fund a PhD researcher and other research at the Queen Mary University of London.
3. The grant from James Clifford Campling Trust was made with the express direction to fund research into Glioblastoma Multiforme (at Queen Mary University of London).
4. The grant from Ollie’s Fund was made with the express direction to fund Dr Sara Badodi, Postdoctoral Research Fellow at the Queen Mary University of London over a period of five years.
5. The grant from the Garfield Weston Foundation was made with the express direction to fund research into Glioblastoma Multiforme (at Queen Mary University of London).
6. The grant from the Children’s Brain Tumour Research Fund was made with the express direction to fund research into Glioblastoma Multiforme (at Queen Mary University of London).
7. The grant from the Brain Tumour Research Bright Club members was made with the express direction to fund a clinical research fellow at Imperial College London.
8. The grant from Bolt Burden Kemp was made with the express direction to fund brain tumour research at the University of Plymouth
9. The grant from The Bryan Guinness Charitable Trust was made with the direction to fund charitable activities.
10. The grant from Belron Ronnie Lubner Charitable Foundation was made with the express direction to fund Brain Tumour Research charitable activities.
44 Brain Tumour Research – Registered Charity 1153487 (England and Wales) and SC046840 (Scotland). Company Limited by Guarantee 08570737. Report of The Trustees and Accounts, Year Ended 30th June 2022
At the start of the year £ Income and gains £ Expenditure and losses £ Transfers £ At the end of the year £ Restricted funds: 1. The Danny Green Fund – 5,480 (5,480) – –2. In Sue’s Name – 36,037 (36,037) – –3. James Clifford Campling Trust – 1,000 (1,000) – –4. Ollie’s Fund 150,000 – (75,000) – 75,000 5. Garfield Weston Foundation – 140,000 (46,667) – 93,333 6. Children’s Brain Tumour Research Foundation – 114,000 (114,000) – –7. Bright Club – 35,400 (35,400) – –8. Bolt Burden Kemp – 2,740 (2,740) – –9. The Bryan Guinness Charitable Trust – 10,000 (10,000) – –10. Belron Ronnie Lubner Charitable Foundation – 1,000 (1,000) – –Total restricted funds 150,000 345,657 (327,324) – 168,333 General funds (308,399) 4,968,981 (3,729,025) – 931,557 Total unrestricted funds (308,399) 4,968,981 (3,729,025) – 931,557 Total funds (158,399) 5,314,638 (4,056,349) – 1,099,890
20 Reconciliation of net income to net cash flow from operating activities
21 Analysis of cash and cash equivalents
22 Operating lease commitments
The Charity’s total future minimum lease payments under non-cancellable operating leases is as follows for each of the following periods:
23 Legal status of the Charity
The Charity is a company limited by guarantee and has no share capital. The liability of each member in the event of winding up is limited to £1.
Brain Tumour Research – Registered Charity 1153487 (England and Wales) and SC046840 (Scotland). 45 Company Limited by Guarantee 08570737. Report of The Trustees and Accounts, Year Ended 30th June 2022
At 1st July 2021 £ Cash flows £ Other changes £ At 30th June 2022 £ Cash at bank and in hand 2,360,973 2,983,244 – 5,344,217 Total cash and cash equivalents 2,360,973 2,983,244 – 5,344,217
Property 2022 £ Property 2021 £ Less than one year 98,754 81,638 One to five years 172,820 224,506 271,574 306,144
2022 £ 2021 £ Net income for the reporting period (as per the statement of financial activities) 1,357,860 1,258,289 Depreciation charges 26,934 28,625 (Gain) / loss on investments 88 (67) (Increase) in stocks 17,875 (19,954) (Increase)/Decrease in debtors 3,742 (68,123) Increase in creditors 1,606,042 610,104 (Increase)/decrease in debtors over one year in advance 16,863 (21,362) Net cash provided by / (used in) operating activities 3,029,404 1,787,512









46 Brain Tumour Research – Registered Charity 1153487 (England and Wales) and SC046840 (Scotland). Company Limited by Guarantee 08570737. Report of The Trustees and Accounts, Year Ended 30th June 2022 Easy it’s not.
Brain tumour research – a tough nut to crack.
Our Fundraising Groups




Our Fundraising Partners












































Brain Tumour Research – Registered Charity 1153487 (England and Wales) and SC046840 (Scotland). 47 Company Limited by Guarantee 08570737. Report of The Trustees and Accounts, Year Ended 30th June 2022 The Lorn’s Legacy FUNDRA SING FOR BRA N TUMOUR RESEARCH Leah’s Fairy Fund MARK “BOMBER” LANCASTER TRUST RIDE4SIMON nd a s ginsuppo b aint mour e a h T EAM H OPKIN S WINNING FORDD
NEUROPATHOLOGY
NEURODEGENERATIVE DISEASE
DIVISION OF
AND DEPARTMENT OF
Our Member Charities
Together we will find a cure
Our Centre of Excellence Partners
Brain Tumour Research, Suite 37, Shenley Pavilions, Chalkdell Drive, Shenley Wood, Milton Keynes MK5 6LB www.braintumourresearch.org Tel: 01908 867200 info@braintumourresearch.org Registered charity number 1153487 (England and Wales) SC046840 (Scotland). Company limited by guarantee number 08570737. Annual Report and Financial Statements for the Year Ended 30th June 2022

Professor Oliver Hanemann the University of Plymouth
Professor Oliver Hanemann the University of Plymouth


















































 Wendy Fulcher Chairman of the Trustees
Wendy Fulcher Chairman of the Trustees



















































